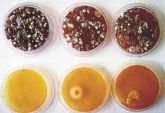

Рубрика "Чистые помещения"
2-3/2022 (88-89) март-июнь
- Очистка. Терминология и ключевые вопросы

Очистка в фармацевтической промышленности, производстве медицинского оборудования и смежных отраслях – сложная, обширная междисциплинарная тема. Очистка необходима во многих областях производства, она связана со многими отраслевыми вопросами...
- Будущее валидации

Ситуация в мире резко изменилась, но, несмотря на это, можно с уверенностью полагать, что общую тенденцию на цифровизацию уже ничто не остановит. Однако цель данной статьи – не построение прогнозов, а рассмотрение объективного базиса, имеющегося в фармацевтической отрасли в настоящий момент.
- Стандартные процедуры: снизить, перепроектировать, реконструировать

Существует ряд факторов, влияющих на контроль частиц в чистых помещениях. Предварительный анализ некоторых важных соображений относительно стандартных операционных процедур может иметь большое значение не только для чистых помещений, но и для всей планеты.
6/2021 (86) ноябрь-декабрь
- Проектирование фармацевтических чистых помещений и ISO 14644-16

Чистые помещения и контролируемые среды все чаще используются во многих отраслях (включая фармацевтическую промышленность). Важным вопросом являются эксплуатационные расходы, связанные с потреблением энергии в чистых помещениях, и, следовательно, поиск мер по снижению энергопотребления.
5/2021 (85) сентябрь-октябрь
- Особенности пылеудаления в чистых помещениях

Для выбора подходящего оборудования необходимо учитывать характер пыли и нормативно-правовое регулирование её сбора и удаления, а также рассматривать классификацию устройств и технологию фильтрации. Дэниел Тук (компания Archer) напоминает, что чем ниже предельно допустимая концентрация (ПДК, Threshold Limit Value - TLV) пыли, тем выше риск этой пыли для здоровья...
- Особенности калибровки счётчиков аэрозольных частиц по стандарту ГОСТ Р ИСО 21501-4

Стандарт ГОСТ Р ИСО 21501-4 «Получение распределения частиц по размерам. Оптические методы оценки отдельных частиц. Часть 4. Счётчики частиц в воздухе для чистых помещений, работающие на принципе рассеяния света» появился в нашей стране в 2012 году как перевод международного стандарта ISO 21501-4...
4/2021 (84) июль-август
- Инновации в инфраструктуре чистых помещений с учётом нужд клеточной и генной терапии

Биофармацевтические препараты изменили методы лечения, но наряду с этим качественным изменением терапевтических возможностей возникает необходимость аналогичного изменения парадигмы в возможностях производства. В той статье Майк Йорниц, президент и генеральный директор компании G-CON Manufacturing Inc., делает акцент на том, как должна развиваться инфраструктура чистых помещений в соответствии с постоянно меняющимися потребностями отрасли.
- Мобильные контролируемые среды класса 8 ISO

Контролируемые среды являются достаточно востребованными для создания свободных от COVID зон; что применение нашлось даже некоторым нетрадиционным местам. Компания Guardtech Cleanrooms рассматривает проблемы, связанные с такими мобильными объектами: от фургонов на стоянках компаний до транспортных контейнеров на близлежащих газонах.
3/2021 (83) май-июнь
- Самокалибрующиеся термометры для применения в автоклавах медицинского назначения

Обычно температурный датчик в автоклаве медицинского назначения калибруется один раз в год. Если датчик оказывается неточным, все партии продукции, прошедшие обработку в автоклаве с момента предыдущей калибровки, должны пройти проверку.
2/2021 (82) март-апрель
- Внедрение передовых практик мониторинга, основанного на анализе рисков, для современных фармацевтических предприятий

Мониторинг параметров среды - это один из наиболее эффективных инструментов контроля состояния чистых помещений и зон.
1/2021 (81) январь-февраль
- Особенности разработки и внедрения GxP-релевантных компьютеризированных систем

В настоящее время словосочетание «целостность данных» является, пожалуй, одним из самых цитируемых, когда речь идёт о современных требованиях GxP. Это неудивительно, если принять во внимание решительный настрой регуляторов – FDA, MHRA, EMA и др...
- Проектирование лабораторий после COVID-19

Главной целью проектирования лабораторий всегда была интеграция пользователей лабораторий с оборудованием и опасными материалами. Пандемия COVID-19 внесла новый элемент в проектирование лаборатории – как защитить сотрудников от вирулентных инфекционных заболеваний...
6/2020 (80) ноябрь-декабрь
- 12 важнейших шагов к созданию фармацевтического чистого помещения

Чистые помещения, независимо от их назначения, требуют пристального внимания как на этапе проектирования, так и при эксплуатации.
- Ближайшее десятилетие чистых помещений

Сборно-разборные и модульные чистые помещения используются все чаще, но строительство традиционными методами пока доминирует.
- Экономия на воздухе для чистых помещений

Экономия на воздухе для чистых помещений
Анализ показывает, как предприятия могут получать выгоду от более низкой кратности воздухообмена без риска несоответствия требованиям по чистоте воздуха.
5/2020 (79) сентябрь-октябрь
- Кондиционирование воздуха на практике Как системы воздухоподготовки могут быть источником значительного снижения расхода средств и выбросов углекислого газа

Если бы вы могли снизить выбросы CO2 на 1000 тонн и сэкономить тысячи долларов ежегодно, повысив надёжность вашей лаборатории, Вы бы сделали это?
4/2020 (78) июль-август
- Руководство по существу: чистые помещения и чистые зоны

Хотя чистые помещения и чистые зоны существуют уже более полувека, в результате изменений нормативных требований, экономических тенденций и новых технологий они стали как никогда большими и сложными.
- Мониторинг наноразмерных частиц в чистых помещениях: ISO 14644-12

Данная статья представляется читателям из серии информационных материалов, подготовленных руководителями ISO/TC 209 для разъяснения и продвижения расширяющегося набора стандартов, разрабатываемых ISO/TC 209.
2-3/2020 (76-77) март-июнь
- Проект ISO 14644-17: Осаждение частиц

Кус Агрикола, член международного комитета, работающего над новым стандартом ISO, в котором рассматривается осаждение частиц, обсуждает параметр непосредственно связывающий чистоту воздуха и вероятность загрязнения поверхности.
1/2020 (75) январь-февраль
- Сжатый воздух - важный объект спецификации чистого помещения, о котором забывают

Для обеспечения качества и безопасности продукции фармацевтические компании должны применять стандарты качества и планы мониторинга для производственных процессов. Однако при оценке рисков часто пропускают системы сжатого воздуха, которые могут являться критической составляющей производственного процесса или среды чистого помещения. Это, в частности, связано с отсутствием нормативных документов, которые могли бы объяснить производителю как именно осуществлять мониторинг таких систем. Один из путей внести ясность в эту ситуацию - использовать стандарты для чистых помещений для систем сжатого воздуха.
- Расчет вентиляционной установки для чистых помещений

Проектирование вентиляционной установки для чистых помещений – не простой процесс. Для этого требуется сочетание инженерных навыков, понимания потенциальных механизмов генерации частиц и опыта.
Количество подаваемого воздуха различно для помещений класса 6 ISO и класса 8 ISO. Это значит, что вентиляционная система должна иметь возможность подготовки более чем двойного объёма воздуха. Однако классификация сама по себе не достаточна для расчета потоков воздуха.
6/2019 (74) ноябрь-декабрь
- Квалификация чистых помещений

Обновленное руководство GMP акцентирует внимание на контроле загрязнения, влияющем на квалификацию эксплуатации чистых помещений.
- Системный подход к изучению потоков воздуха в операционных комнатах

Исследования, проводимые в Германии, направлены на определение оптимальных потоков воздуха в операционных комнатах с целью профилактики послеоперационных раневых инфекций. Бенджамин Зильке, Валерия Хофер, Хансйорг Ротеудт, Энн Хартманн и Мартин Кригель анализируют эту проблему.
- Контроль содержания аэрозолей в воздушной среде герметичного помещения в четы-рехмесячном изоляционном эксперименте SIRIUS-19

НИЦ «Курчатовский институт», г.Москва
Специалистам по технологии чистоты хорошо известно, что в воздушной среде любого замкнутого помещения – в промышленном цехе, концертном зале, офисе, квартире - накопление микрозагрязнений на несколько порядков превышает аналогичный процесс в помещениях с организованным воздухообменом и системой воздухоочистки (за счет застойных зон и генерации аэрозолей внутри помещения) [1-2]. Из всего множества замкнутых помещений выделяется особая группа – полностью герметичные обитаемые помещения, у которых отсутствует контакт с атмосферой (но, разумеется, есть система воздухоподготовки для поддержания жизнедеятельности находящихся внутри людей). Наиболее типичными примерами таких объектов являются разного рода убежища, подводные лодки, самолеты и космические станции [3].
5/2019 (73) сентябрь-октябрь
- Важность использования документации для чистых помещений

Чувствительная природа чистых помещений означает, что такие повседневные предметы, как принтеры, блокноты и ручки становятся потенциальными загрязнителями, которые выделяют мельчайшие частицы, угрожая чистоте помещения. Для обеспечения безопасного функционирования чистых помещений такие предметы должны быть изготовлены из специальных незагрязняющих материалов.
- Тренды в индустрии чистых помещений: скоростные рулонные ворота и двустворчатые двери

Фармацевтическая отрасль является одной из самых требовательных в производственном секторе в части контроля условий, а чистые помещения являются наиболее контролируемыми областями. Профилактика проникновения загрязняющих веществ в процессе доступа в чистые помещения имеет решающее значение, независимо от размера и сложности самих помещений. И скоростные ворота играют в этом важную роль.
- Взаимосвязь между системами мониторинга и планированием непрерывности бизнеса

Данные, получаемые при помощи систем мониторинга чистых помещений являются критически важными для фармацевтических производств. Крайне важно обеспечить надлежащую техническую поддержку для таких систем.
4/2019 (72) июль-август
- Контроль целостности HEPA-фильтров: практический подход

Контроль целостности HEPA-фильтров: практический подход
Фильтрация воздуха в асептических производственных зонах имеет решающее значение для поддержания чистоты производственной среды. Хесус Касас советует, как проводить контроль НЕРА-фильтров после их установки на предприятии.
- Моделирования воздушных потоков и оптимизация конструкции чистого помещения

В течение многих лет для определения требуемого расхода потока воздуха для достижения определенного уровня чистоты, или компенсации тепловой нагрузки, применяются эмпирические методы.
3/2019 (71) май-июнь
- Краткое руководство по методам определения размеров частиц

Важно понимание того, что делает данный метод определения размеров частиц подходящим для конкретного применения.
Потребность в определении размеров частиц является сходной для многих отраслей промышленности, однако методы получения этой информации различаются. Это не случайность. В течение многих десятилетий инженеры разрабатывали и оттачивали технологии определения размеров частиц – как твердых, так и жидких – и в настоящее время имеется большой выбор доступных методов, в том числе уникальные решения для специфических случаев. Различные методы приводят к отличающимся результатам, что делает возможным получение большого числа разных размеров частиц для данного образца.
2/2019 (70) март-апрель
- Как работать со счетчиком частиц, чтобы получить достоверные данные

Джейсон Келли, вице-президент по сервисному обслуживанию, компания Lighthouse Worldwide Solutions, раскрывает лучшие приемы работы со счетчиками частиц, которые помогут пользователям снизить вероятность нарушения целостности и точности данных и минимизировать возможные последствия.
2/2018 (66) апрель-июнь
- Чистые помещения, контролируемые среды и их метрологическое обеспечение

Решение задач по обеспечению функционирования чистых помещений, так же как и задач по обеспечению приемо-сдаточных испытаний созданных и предъявляемых к приемке чистых помещений, невозможно без обеспечения единства измерений более двух десятков контролируемых параметров, характеризующих эти помещения. Система обеспечения единства измерений параметров чистых помещений и контролируемых сред реализуется посредством передачи единиц величин в соответствии с государственными поверочными схемами (ГПС) от государственных первичных эталонов (ГЭТ) единиц величин, вторичными и рабочими эталонами рабочим средствам измерений этих величин, а также системой национальных и межгосударственных стандартов и методик на методы и средства передачи единиц величин.
- Проект новой версии Приложения 1 GMP (EC). Глава 5. Помещения

В предыдущем номере нашего журнала вашему вниманию был представлен аналитический обзор всего содержания проекта новой версии Приложения 1 GMP (EC). Две главы этого документа - «Помещения» и «Мониторинг окружающей среды» - имеют самое непосредственное отношение к тематике нашего журнала, поэтому мы приняли решение опубликовать их полный текст. В этом номере вы познакомитесь с главой 5, а в следующем - главой 9, касающейся мониторинга окружающей среды.
- Стандарт ISO/DIS 14644-3. ЧИСТЫЕ ПОМЕЩЕНИЯ И СВЯЗАННЫЕ С НИМИ КОНТРОЛИРУЕМЫЕ СРЕДЫ. Часть 3: Методы испытаний

Для того чтобы классифицировать чистое помещение, следует провести одно или несколько испытаний, связанных с классификацией чистоты для чистых помещений и чистых зон.
3/2017 (63) июль-сентябрь
- Мобильный комплекс бактериологической лабораторной диагностики от Миасского завода медицинского оборудования
- Выбор портативных автоматических приборов для отбора проб воздуха согласно требованиям GMP
Выбор правильного прибора для автоматического отбора проб воздуха не всегда так прост, как может показаться. Директор по системам компании Lighthouse Worldwide Solutions (США) Джейсон Келли объясняет почему...
2/2017 (62) апрель-июнь
- Комплексы биологической безопасности от МЗМО
В России усилят контроль над ветеринарной и фитосанитарной безопасностью. С этой целью в стране будут построены новые межобластные ветеринарные лаборатории, а действующие учреждения - модернизируют - Пример выдающегося достижения в области проектирования чистых помещений для лабораторий

Автор рассказывает о реализации новаторского подхода в проектировании химико-аналитической лаборатории компании «GlaxoSmithKline» в университете г. Ноттингем
- Компания S-LAB представляет рациональные и сбалансированные проекты лабораторий будущего
На семинаре под названием «Лаборатории будущего» (Labs of the future), прошедшем в Ноттингеме, компания S-LAB продемонстрировала лучшее решение по разработке гибких, сбалансированных лабораторий с низким «углеродным следом»*, подходящие как для широкомасштабных образовательных программ для студентов, так и исследовательских коммерческих проектов. - Применение лучших практик для контроля загрязнений

Обучение основам контроля загрязнений
1/2017 (61) январь-март
- Аспекты мониторинга для чистых помещений фармацевтической промышленности

Большинство чистых помещений имеют простую планировку, помещения для смешения или компаундинга соединяются с тамбуром. Для помещений, где не был предусмотрен мониторинг, существуют решения, позволяющие при этом проводить контроль основных параметров воздушной среды, который заключается в измерении перепада давления, температуры и относительной влажности.
- Анализ рисков для стареющих фармацевтических предприятий

Появились новые нормативные особенности регулирования, затрагивающие фармацевтические предприятия, которые относятся к возрастной группе основных фондов: риски связанные со старением производственных мощностей.
- Осаждение взвешенных в воздухе частиц в чистых помещениях. Взаимосвязь между скоростью осаждения и концентрацией частиц в воздухе

Данная статья исследует зависимость между измеренной счетчиком частиц концентрацией частиц и скоростью осаждения (PDR - particle deposition rate) частиц на единицу площади поверхности в чистых помещениях на основании знаний о скорости седиментации* частиц в воздухе.
- Современные чистые помещения от МЗМО

Технологии чистых помещений в России более 25 лет. Одним из пионеров этой отрасли в России является Миасский завод медицинского оборудования (МЗМО). Разработку оборудования для высокоэффективной очистки воздуха специалисты предприятия начали еще в 90-х годах и продолжают совершенствование своей продукции
- Стандарты при проектировании, строительстве и монтаже чистых помещений

Чистые помещения являются жизненно важной частью в микроэлектронной промышленности, особенно при производстве полупроводников. Для управления и обеспечения качества продукции в этих областях используются специальные стандарты, которыми руководствуются при строительстве и эксплуатации чистых помещений.
4/2016 (60) окрябрь-декабрь
- Идти в ногу с индустрией фильтрации воздуха

О новом руководстве IEST по фильтрации воздуха в чистых помещениях и связанных с ними контролируемых средах
- О журнале, метрологии и стандартизации для чистых помещений и технологических сред

«Каждая вещь известна лишь в той степени, в которой её можно измерить»
У. Кельвин
- Метрологическое обеспечение измерений дисперсных параметров аэрозолей, взвесей и порошкообразных материалов

В статье описаны методы измерений, используемые для воспроизведения и передачи единиц дисперсных параметров аэрозолей, взвесей и порошкообразных материалов в эталонной аппаратуре ФГУП «ВНИИФТРИ», а также аппаратурный состав и результаты сличений
- В ногу с новыми стандартами

Реферат статьи Сьюзан Биркс (издание Cleanroom Technology, август 2016
- Стандарт ISO 14644-13. Чистые помещения и связанные с ними контролируемые среды. Часть 13: Очистка поверхностей для достижения определённых уровней чистоты в рамках классификации по частицам и химическим загрязнениям

Окончание. Начало в номерах 2 и 3 2016 года
- Этот ужасный английский язык. Продвигаясь по частям стандарта ISO 14644

Статья опубликована в журнале Controlled Environments, июль-август 2016 (www.cemag.us)
2/2016 (58) апрель-июнь
- Влияние принудительной вентиляции и одежды на взвешенные в воздухе микроорганизмы и раневой сепсис в операционных палатах (часть 2)

В течение 50-ти лет Вильям Уайт исследовал роль принудительной вентиляции в минимизации микробиологических загрязнений. Первые 25 лет своей деятельности он посвятил госпиталям, а вторые 25 - промышленным чистым помещениям. Его работа, связанная с операционными палатами, проходила в период важных изменений в конструкции ламинарных вентиляционных систем, когда было обнаружено их влияние на послеоперационный раневой сепсис. Нередко подробности того, как развиваются идеи ученого, долго работающего в какой-то области науки, а также то, что он испытывает, проверяя их на практике, остаются за пределами научных публикаций. Поэтому записки Вильяма Уайта об этом времени очень интересны и информативны. Его воспоминания поделены на две части, первая часть была опубликована в предыдущем номере нашего журнала, а вторая часть предоставляется вашему вниманию
- Новое в стандартизации чистоты помещений

Чистые помещения - это помещения, в которых строжайше контролируется загрязнение воздуха. Контроль загрязнённости жизненно необходим в таких отраслях экономики, как пищевая промышленность (производство продуктов питания), фармацевтика (изготовление лекарств), электронная, космическая и многие другие отрасли промышленности.
- Стандарт ISO 14644-13. Чистые помещения и связанные с ними контролируемые среды. Часть 13: Очистка поверхностей для достижения определённых уровней чистоты в рамках классификации по частицам и химическим загрязнениям

Секретариат технического комитета 209 при IEST опубликовал проект нового стандарта ISO 14644-13: «Очистка поверхностей для достижения требуемого уровня чистоты по частицам и химикатам».
1/2016 (57) январь-март
- Использование информационного моделирования здания для чистых помещений

Текст подготовлен к опубликованию компанией УНИКА по материалам статьи из журнала CleanroomTechnology, сентябрь 2015 (www.cleanroomtechnology.com)
Использование в процессе проектирования информационного моделирования здания делает производство и монтаж конструкций чистых помещений более эффективным, при этом экономятся капиталовложения и время. Автор знакомит читателей с новой технологией проектирования и строительства, а также с возможностями, которые она предоставляет
- Передовые методы обеспечения уровня стерильности на стадиях наполнения/ финишной обработки

Статья опубликована в журнале «BioPharm International», 28 (11) 2015
Два эксперта обсуждают передовые методы достижения надлежащих уровней обеспечения стерильности продукции асептического наполнения
- Проектирование системы мониторинга: 10 главных ошибок и как их избежать

Уже более 10 лет специалисты нашей организации имеют дело с системами мониторинга аэрозольных частиц. Мы их проектируем, устанавливаем или помогаем проектировать и устанавливать, а иногда просто консультируем. И все эти годы вплоть до настоящего времени мы сталкиваемся в общем-то с одними и теми же проблемами у наших заказчиков. Эти самые проблемы возникают не из ниоткуда-то, а являются вполне закономерным следствием ошибок, допущенных при проектировании и монтаже системы мониторинга.
- Новые разработки в области чистых помещений и мониторинга воздушной среды

Статья опубликована в журнале "CLEANRООМ", июль 2015
- Влияние принудительной вентиляции и одежды на взвешенные в воздухе микроорганизмы и раневой сепсис в операционных палатах

В течение 50-ти лет Билл Уайт исследовал роль принудительной вентиляции в минимизации микробиологических загрязнений. Первые 25 лет своей деятельности он посвятил госпиталям, а вторые 25 - промышленным чистым помещениям. Его работа, связанная с операционными палатами, проходила в период важных изменений в конструкции ламинарных вентиляционных систем, когда было обнаружено их влияние на послеоперационный раневой сепсис. Нередко подробности того, как развиваются идеи ученого, долго работающего в какой-то области науки, а также то, что он испытывает, проверяя их на практике, остаются за пределами научных публикаций. Поэтому записки Билл Уайта об этом времени очень интересны и информативны. Его воспоминания поделены на две части, первая из которых и предоставляется вашему вниманию
4/2015 (56) октябрь-декабрь
- Современное моделирование чистых помещений

Вычислительная гидродинамика обеспечивает надёжность процесса производства вакцин. Валидация производства вакцин на новом уровне с применением вычислительной гидродинамики: компания Creaform модернизирует нормативный процесс подтверждения соответствия для чистых сред.
- Возможные последствия введения в действие ISO/DIS 14644-1.2

Каким образом положения этого стандарта влияют на мониторинг состояния чистых помещений в биофармацевтической промышленности?
- Очистка в условиях производства интегральных схем

Постоянно растущее требование к надежности, тенденция к миниатюризации изделий и возрастающее количество неисправностей электронных компонентов, производимых в условиях, не соответствующих требуемым классам чистоты, – все эти факторы...
- Проектирование и строительство чистых помещений с отрицательным давлением

До настоящего времени отсутствует исследование стандартов, нормирующих чистые помещения с отрицательным давлением для приготовления стерильных лекарственных средств...
- Эффективность работы системы вентиляции и кондиционирования воздуха (HVAC) зависит от её чистоты

Задача обеспечения соответствия стандартам уровня чистоты в чистом помещении всегда остается неизменно актуальной. Это требует постоянного...
3/2015 (55) июль-сентябрь
- Модульная конструкция чистых помещений: Главная ценность – в деталях

Статья опубликована на сайте журнала «Controlled Environments» (www.cemag.us)
Одним из достоинств модульной системы чистого помещения является то, что проектировщики и строители, а также конечные пользователи, как правило, в состоянии вести более плановый монтаж, т.к. строительные модули уже заранее были изготовлены в хорошо организованных и контролируемых условиях, обеспечивающих более методичное и системное завершение. Легкость сборки, обеспечиваемая использованием стандартных модульных элементов, помогает превращать очень сжатые сроки в реальные сроки строительства.
- Нержавеющая сталь для фармацевтической промышленности

Статья публикуется с разрешения журнала "Cleanroom Technology", сентябрь, 2014 (www.cleanroomtechnology.com)
Уход за поверхностями из нержавеющей стали осуществляется путем применения надлежащих методов шлифовки и очистки. Найджел Уилкок, Отделение абразивных систем компании «3М», рассуждает о свойствах нержавеющей стали и о том, как наилучшим образом использовать ее преимущества.
- RABS в сравнении с изоляторами. Барьерные технологии в фармацевтическом производстве

Статья опубликована в журнале "ReinRaumTechnik", № 3 2015
В период становления асептического производства одной из целей при проектировании такого типа производств было создание изоляторов, которые позволяют минимизировать загрязнения продукции путем отделения оператора от критической производственной зоны. Этого можно добиться при помощи барьерных систем ограниченного доступа RABS (англ. Restricted Access Barrier Systems) или изоляторов.
- Гибкое применение чистых помещений

Статья опубликована в журнале "Controlled Environments", апрель 2015 (www.cemag.us) Разработка лекарственных форм для перорального применения на ранних клинических стадиях.
- Практики и процедуры работы персонала в чистых помещениях и связанных с ними контролируемых средах (Реферат документа IEST-RP-CC027.2)

Реферат подготовлен по материалам документа IEST-RP-CC027.2. Этот реферат печатается в продолжение публикаций материалов Американского института исследо-ваний окружающей среды и технологий (англ. IEST- Institute of Environmental Sciences and Technology) в целях поддержки технологического и научного уровня наших постоянных читателей. В тексте документа представлены ссылки на справочные материалы, содержащие подробное описание теорий, практик и исследования контроля загрязнений. Из этих материалов читатель, в случае необходимости, сможет получить более подробную информацию. Эти материалы представлены в разделе Литература.
- Одежда для чистых помещений и контролируемых сред (Реферат документа IEST-RP-CC003.4)

Реферат подготовлен по материалам документа IEST-RP-CC003.4. Он предназначен пользователям одежды и разработчикам системы одевания персонала чистого помещения. Он также определяет критерии выбора технических свойств текстильных материалов, методов испытания и процедур, которые входят в систему одевания. С началом публикации можно ознакомиться в предыдущем номере нашего журнала, а этот номер познакомит вас с Приложением В, которое касается проведения различного рода испытаний, применительно к технологической одежде для чистых помещений.
2/2015 (54) апрель-июнь
- Эволюция чистых помещений

Статья опубликована на сайте журнала «Controlled Environments Magazine» (www.cemag.us)
- Чистые помещения и чистота воздуха с точки зрения анализа рисков

Статья опубликована в журнале «Controlled Environments», январь-февраль 2015 (www.cemag.us)
- Как содержать чистое помещение в чистоте

Статья опубликована в журнале «Controlled Environments», январь-февраль 2015 (www.cemag.us)
- Практики и процедуры работы персонала в чистых помещениях и связанных с ними контролируемых средах (Реферат документа IEST-RP-CC027.2)
Реферат подготовлен по материалам документа IEST-RP-CC027.2. - Одежда для чистых помещений и контролируемых сред (Реферат документа IEST-RP-CC003.4)

Реферат подготовлен по материалам документа IЕSТ-RР-СС003.4- Текст реферата в максимальной степени сохраняет порядок изложения материала первоисточника и ввиду большого объема планируется к публикации в нескольких номерах журнала.
1/2015 (53) январь-март
- Повышение энергоэффективности вытяжной установки

Статья опубликована на сайте журнала «Controlled Environments» (www.cemag.us)
Редакция признательна Гайдукову А.Д. за подготовку текста к опубликованию
- Офисные помещения – идеальные объекты для размещения фармацевтического производства
Статья публикуется с разрешения журнала «Cleanroom Technology», июнь 2014 (www.cleanroomtechnology.com)Не всегда существует необходимость в строительстве новых объектов. Компания «GMP Group» демонстрирует, каким образом офисные помещения можно переоборудовать для фармацевтического производства с соблюдением самых высоких стандартов. - Внедрение научного подхода и повышение качества подготовки персонала чистых помещений
Статья опубликована на сайте журнала «Controlled Environments», (www.cemag.us) - Безопасная работа в чистом помещении

Статья опубликована на сайте журнала «Controlled Environments», (www.cemag.us)
- Стандарт ISO 14644-2 ЧИСТЫЕ ПОМЕЩЕНИЯ И СВЯЗАННЫЕ С НИМИ КОНТРОЛИРУЕМЫЕ СРЕДЫ. Часть 2. Мониторинг концентрации частиц для подтверждения характеристик чистого помещения по чистоте воздуха

Окончание. Начало в предыдущем номере
- Стандарт ISO 14644-1. Чистые помещения и связанные с ними контролируемые среды. Часть 1. Классификация чистоты воздуха по концентрации частиц

Окончание. Начало в предыдущем номере
- Базовые стандарты ISO 14644: большие перемены

Напомним, что еще в 2011 году в №№ 1-3 нашего журнала были опубликованы переводы проекта пересмотра стандартов ISO 14644-1 и 14644-2 (редакция DIS 2010 года). Публикация проектов стандарта - обычная практика в работе технических комитетов ISO. Это делается для того, чтобы, во-первых, специалисты, которым предстоит работать по этим документам, заранее познакомились с ними и знали, какие именно изменения ждут их в ближайшем будущем.
- Во власти слов

Дорогие читатели, редакция журнала при подготовке материалов к печати, да и при общении и переписке с читателями довольно часто сталкивается с лингвистическими проблемами, носящим узкопрофессиональный характер, то есть связанными с вопросами технологии чистоты. Это и трудности в подборе правильного перевода терминов, и различие в терминологии, принятой в различных отраслях, и неверное или некорректное употребление терминологии, особенно в материалах рекламного характера. Например, редакции приходилось сталкиваться с многочисленными случаями использования в печатных текстах термина чистые помещения в кавычках, что зачастую ставит специалистов в недоумение. Поэтому мы решили представить вашему вниманию некоторые разъяснения лингвистического характера, которые вылились в небольшую заметку. В составлении ее текста были использованы материалы из книг и выступлений нашего замечательного лингвиста, профессора Михаила Кронгауза.
4/2014 (52) октябрь-декабрь
- Изобретения, которые изменили мир. История создания воздушных кондиционеров

Многие продукты, в том числе мясо, макароны, лекарственные препараты, табак и текстиль значительно улучшили свое качество.
- Эффективность и безопасность при очистке чистых помещений

Уборка и очистка чистых помещений может оказаться трудоемкой, обременительной и сложной процедурой. Эдвард Бекер из компании «Hydroflex OHG» рассказывает о том, как выбор правильной системы для уборки и очистки чистых помещений способен облегчить эту задачу
- Стандарт ISO 14644-2. Чистые помещения и связанные с ними контролируемые среды. Часть 2. Мониторинг концентрации частиц для подтверждения характеристик чистого помещения по чистоте воздуха

Данная часть стандарта ISO 14644 подчёркивает необходимость разработки стратегии мониторинга в дополнение к классификации чистого помещения или чистой зоны согласно ISO 14644-1.
- Стандарт ISO 14644-1. Чистые помещения и связанные с ними контролируемые среды. Часть 1. Классификация чистоты воздуха по концентрации частиц

Чистые помещения и связанные с ними контролируемые среды обеспечивают контроль загрязнений воздуха или поверхностей на уровнях, отвечающих требованиям, надлежащим для проведения чувствительных к загрязнениям процессов.
- Базовые стандарты ISO 14644: большие перемены

В этом номере редакция начинает публикацию переводов проектов новых редакций стандартов ISO 14644-1 и 14644-2.
3/2014 (51) июль-сентябрь
- Рекомендации PIC/S «Приложение 1 к GMP в редакции 2008 г. Интерпретация наиболее важных изменений по производству стерильных лекарственных средств»

Pharmaceutical inspection convention, pharmaceutical inspection co-operation scheme (http://www.picscheme.org)
- Определение требований к оборудованию для пылевого контроля

Статья публикуется с разрешения редакции журнала Qeanroom Technology, февраль 2014 (www.cleanroom-technology.co.uk)
Эффективный пылевой контроль и изоляция обрабатываемых компонентов являются ключевыми требованиями фармацевтического предприятия.
- Планирование модернизации объекта без прерывания производства

Статья публикуется с разрешения редакции журнала Cleanroom Technology, апрель 2013 (www.cleanroom-technology.com.uk)
- Системы мониторинга чистых помещений: краткое руководство по внедрению

Для обеспечения соответствия производственных сред рекомендациям GМР все чаще и чаще используются специализированные системы мониторинга. Матиас Албер шаг за шагом рассматривает этапы планирования и внедрения такой системы
- Стандарты строительных работ: снижение риска загрязнения в условиях проведения операций

Материал к публикации подготовлен специалистами компании ООО «УНИКА Инжиниринг»
- Совершенствование стандарта по биозагрязнениям

Статья публикуется с разрешения редакции журнала Cleanroom Technology, апрель 2014 (www.cleanroom-technology.co.uk)
2/2014 (50) апрель-июнь
- Рекомендации ВОЗ для проектирования и обслуживания систем вентиляции при производстве твёрдых лекарственных форм

Материал к публикации подготовлен специалистами компании ООО «УНИКА Инжиниринг»
- Требования к защите продукции при проектировании производства активных фармацевтических субстанций

Несмотря на неблагоприятную для России рыночную ситуацию, сложившуюся на международном рынке в производстве активных фармацевтических субстанций (АФС), в нашей стране все еще остаются действующие производства АФС, а также создаются новые участки для производства АФС.
- Практические рекомендации для мониторинга частиц в воздухе чистых помещений, в барьерных системах ограниченного доступа (RABS) и в изоляторах

Статья опубликована в журнале Pharmaceutical Engineering, сентябрь/октябрь 2013, том 33, № 5
Эта статья написана в качестве руководства по разработке и установке системы мониторинга концентрации аэрозольных частиц в производственных чистых помещениях и зонах.
- Разделительные устройства с очисткой воздуха и изолированные зоны

Уважаемые читатели, редакция сочла целесообразным повторить публикацию этой главы из книги В.Уайта, чтобы предварить очень важную статью, посвященную практическим рекомендациям мониторинга частиц в чистых помещениях, изоляторах и барьерных системах ограниченного доступа
1/2014 (49) январь-март
- К вопросу о понятии «рециркуляция» при проектировании чистых помещений

Рассматривая проекты и технические решения в области создания помещений и зон с контролируемой воздушной средой, приходится довольно часто сталкиваться с непониманием инженеров-разработчиков систем вентиляции и кондиционирования воздуха...
- Проектирование производств для асептического розлива

Статья публикуется с разрешения редакции журнала Cleanroom Technology, март 2013 (www.deanroom-technology.co.uk)
Китайская народная республика недавно перешла от американских к европейским правилам GMP.
- Научно обоснованный подход к выбору фильтров очистки воздуха. Реферат статьи

Опубликовано по материалам сайта www.camfil.co.uk
- Факты и вымыслы в метрологии чистых помещений

Статья опубликована в журнале Journal of the IEST, том 53, № 1, 2010
Предлагаемая вашему вниманию статья носит ярко выраженный дискуссионный характер и никоим образом не должна рассматриваться читателями как прямое руководство к действию.
4/2013 (48) октябрь-декабрь
- Пожаро- и взрывобезопасность в чистых помещениях

Использование опасных веществ и процессов в чистых помещениях означает необходимость борьбы с рисками пожара или взрыва. Дьюри Барблан рассматривает проблемы безопасности и предлагает возможные их решения.
- Из истории физики аэрозолей

Нет такой стороны жизнедеятельности человека, которая не зависела бы от аэродисперсных систем. Человеку, равно как и любому живому существу, чтобы жить, необходимо дышать.
- Проект стандарта ISO 14644-12. Чистые помещения и связанные с ними контролируемые среды. Часть 12: Классификация чистоты воздуха по концентрации наноразмерных частиц

Закачивая в этом номере публикацию проекта стандарта ИСО 14644-12, редакция еще раз обращает внимание читателей на то, что данный документ не является окончательным текстом стандарта.
3/2013 (47) июль-сентябрь
- Чистые помещения от «Фармстронг» для «РМ Нанотех»

3 сентября 2013 г. один из крупнейших строительных объектов компании «Фармстронг» - завод «Русские Мембраны Нанотех» был запущен в эксплуатацию.
- Проект стандарта ISO 14644-12 Чистые помещения и связанные с ними контролируемые среды. Часть 12: Классификация чистоты воздуха по концентрации наноразмерных частиц

ИСО (ISO - Международная организация по стандартизации) - международное объединение национальных организаций по стандартизации. Подготовка международных стандартов обычно проводится техническими комитетами ИСО.
- Автоматизированная система мониторинга параметров чистых помещений

Одной из главных задач, возникающих после монтажа и ввода в эксплуатацию комплекса чистых помещений, является последующий непрерывный мониторинг их параметров и архивирование полученных данных.
- «Мистер чистота»

Современные чистые помещения (ЧП) воспринимаются многими как нечто естественное, возникшее в результате развития инженерной мысли. Однако, это совсем не так.
2/2013 (46) апрель-июнь
- Чистота, доступ посредством системы безопасности

Статья печатается с разрешения редакции журнала Controlled Environments, December 2012 (www.cemag.us)
- Рекомендации по созданию систем мониторинга чистоты воздуха на основе датчиков Lighthouse

Статья подготовлена на основе доклада, сделанного на конференции «GEP-RUSSIA-2013: Надлежащая инженерная практика» (Москва, 14-15 февраля 2013 г.)
- Сравнение характеристик воздушных фильтров

Статья содержит материалы технического доклада, представленного фирмой AAF на симпозиуме ICCCS 2012 в Цюрихе (Швейцария) и посвящена сравнительным исследованиям двух видов материалов для фильтров НЕРА – традиционной стеклобумаги и листового материала из ePTFE (политетрафторэтиленовых) волокон.
- Фильтры для чистых помещений

Статья публикуется с разрешения редакции журнала Controlled Environments, February 2013 (www.cemag.us) Редакция благодарит Кадомцева Г.М., зам. Ген. директора ЗАО «Фильтр» за подготовку текста к опубликованию
1/2013 (45) январь-март
- Основные принципы проектирования и эксплуатации экспериментальнобиологических клиник (Вивариев)

Материал для публикации подготовлен компанией ООО «УНИКА инжиниринг»
4/2012 (44) октябрь-декабрь
- Планировочные решения и классификация чистых помещений по требованиям GMP

Нахождение конкретных планировочных и технологических решений при проектировании производственного участка представляет собой творческую задачу, требующую от инженеров-технологов высокой квалификации и понимания как специфики технологических процессов, так и знания других многочисленных требований.
3/2012 (43) июль-сентябрь
- Бактерицидное покрытие для контролируемых сред

Материал предоставлен компанией ООО «Ингермакс»
- Метод проведения испытаний на выделение летучих органических соединений

При выборе материалов для использования в чистых помещениях необходимо принимать во внимание уровни выделения из них летучих органических веществ.
- О некоторых аспектах классификации чистых помещений

Статья посвящена теме определения класса чистоты воздушной среды чистого производственного помещения в зависимости от требований реализуемого в нем технологического процесса.
- Оценка стоимости строительства производства

Чтобы обеспечить прибыльность фармацевтического, биофармацевтического производства или научно-исследовательского комплекса, при его проектировании необходим детальный анализ расходов
2/2012 (42) апрель-июнь
- Наливные полы: пять простых шагов для вашего проекта напольного покрытия

Проект новых или восстанавливаемых наливных покрытий пола или финишной отделки ограждающих конструкций стен материалами на основе полимерных смол может показаться чрезвычайно сложным на начальной стадии планирования таких работ.
- 15 факторов, влияющих на выбор проекта и стоимость строительства чистых помещений

Четкое представление о производственном процессе, который будет осуществляться в планируемом помещении, является непременным условием для выбора эффективного и рентабельного проекта
- Что нужно знать при выборе проекта чистого помещения

Существует множество факторов, которые следует учитывать в процессе принятия решения о необходимости использования чистых помещений или зон в вашем производственном процессе.
- Краткий обзор производств, которые требуют контроля загрязнений технологической среды

Продукты и процессы во многих высокотехнологичных отраслях промышленного производства могут подвергаться серьезному риску повреждения из-за наличия аэрозольных частиц, частиц пыли, химических испарений, электростатических разрядов и других видов загрязнителей технологической среды.
1/2012 (41) январь-март
- Пять советов по правильному выбору фильтров для высокоэффективной фильтрации воздуха

Система фильтрации является ключевым звеном обеспечения чистоты воздуха в чистых зонах, будь то операционные палаты в больнице или сборочная линия полупроводникового производства.
4/2011 (40) октябрь-декабрь
- WI-КЛИМАТ – качество без проводов

Производство лекарственных средств и медицинской продукции включает в себя множество стадий, на каждой из которых контроль качества сырья и условий производства должны быть согласованы с действующими стандартами качества.
- Модульные чистые помещения с гибкими стенками

Модульные чистые помещения с гибкими стенками проектируются таким образом, чтобы обеспечивать функциональность и низкую стоимость чистой зоны, сохраняя при этом все преимущества модульной конструкции.
- Обзор документов с практическими рекомендациями по контролю загрязнений

Отрасль чистых помещений обращается за стандартами и практическими рекомендации к двум основным источникам: Институту исследования окружающей среды и технологии (Institute of Environmental Sciences and Technology - IEST) и Международной организации по стандартизации (International Organization for Standartization - ISO).
3/2011 (39) июль-сентябрь
- Стандарт ИСО 14644-1 Чистые помещения и связанные с ними контролируемые среды Часть 1: Классификация чистоты воздуха по концентрации частиц

Продолжаем публикацию изменений в серии стандартов ИСО 14644. В этом номере мы публикуем перевод заключительных разделов предварительной версии части 1 этого стандарта (начало см. №2/2011 нашего журнала).
1/2011 (37) январь-март
- Стандарт ИСО 14644-2 Чистые помещения и связанные с ними контролируемые среды Часть 2: Требования к мониторингу и периодическому контролю для подтверждения постоянного соответствия стандарту ИСО 14644-1

Данная часть стандарта ИСО 14644 устанавливает требования к периодическому контролю и мониторингу чистых помещений или чистых зон для...
- Изменения в серии стандартов ИСО 14644

Весной 2011 г. должно произойти событие, имеющее чрезвычайно важное значение для всего международного сообщества специалистов, работающих с чистыми производственными помещениями...
- Стандарт ИСО 14644-9 Чистые помещения и связанные с ними контролируемые среды Часть 9: Классификация чистоты поверхности по концентрации частиц

Для размеров частиц, лежащих за пределами классификации, используется дифференциальный дескриптор. Этот дескриптор также можно использовать для определения специфических диапазонов размеров частиц. В этих случаях дескриптор может служить как дополнение к стандартной классификации.
4/2010 (36) октябрь-декабрь
- Очистка воздуха, подаваемого в помещения

Атмосферный воздух всегда содержит какие-либо загрязнения, связанные с различными природными процессами на нашей планете (эрозия почв, вулканические загрязнения и т.п.).
- Стандарт ИСО 14644-9 Чистые помещения и связанные с ними контролируемые среды Часть 9: Классификация чистоты поверхности по концентрации частиц

Уважаемые читатели, по уже установившейся практике, мы стараемся знакомить специалистов с самыми последними нормативными документами, касающимися технологической чистоты.
- Изменения, влияющие на требования GMP EC и CGMP FDA к содержанию нежизнеспособных частиц в чистых помещениях

GMP ЕС и cGMP FDA устанавливают уровни чистоты по содержанию нежизнеспособных частиц в фармацевтических чистых помещениях. По вопросу методов определения этих уровней чистоты оба документа отсылают читателя к группе стандартов ИСО 14644.
- Аэрозольная безопасность

Из воздушной среды чистого помещения должны удаляться частицы. Но удаление тех из них, которые могут воспроизводить себя, становится трудновыполнимой частью этой задачи.
3/2010 (35) июль-сентябрь
- Опыт компании «ФАРМСТРОНГ» при строительстве фабрики для южнокорейского холдинга LOTTE GROUP

В сентябре 2010 года состоялся торжественный запуск фабрики Lotte Confectionery Ltd, входящей в состав южнокорейского холдинга Lotte Group, который объединяет компании пищевой, химической, электронной промышленности, строительной и информационной отрасли, а также сферы развлечений.
- Основные различия чистых помещений для полупроводниковой и биотехнологической отраслей промышленного производства

Дерик Хаддад, генеральный директор созданной в 2004 г. Компании Haddad-Wylie Industries (Питтсбург, Пенсильвания). Начав свою деятельность в области строительства чистых помещений в Силиконовой Долине в Калифорнии...
2/2010 (34) апрель-июнь
- Технологическая одежда и электростатическая безопасность чистых производственных помещений

Цель этой работы - представить данные изучения антистатических свойств тканей различных производителей для одежды чистых помещений, оценить достоверность результатов, полученных различными методами и попытаться найти причину различия в антистатических свойствах тканей, предлагаемых различными производителями
- Модульные чистые помещения

Реферат статьи Кевина Вейста из журнала Controlled Environments, апрель 2010
1/2010 (33) январь-март
- Возможности улучшения систем ионизации чистых помещений

Текст статьи с сокращениями публикуется с разрешения журнала CleanRoom, September 2007 (www.cleanrooms.com). редакция благодарит Просия А.Д., начальника отдела развития систем инфраструктур ОАО «НИИмЭ и микрон», г. Зеленоград, за подготовку текста к опубликованию
3-4/2009 (31-32) июль-декабрь
- Актуальное интервью

В нашей стране впервые построен и вводится в эксплуатацию цех по производству сверхбольших интегральных микросхем (СБИС) с размерами элементов 0,18 - 0,15 мкм.
- Инвентаризация биологической лаборатории и разработка плана контрольных мероприятий позволяют снизить риски для персонала

Контроль за нераспространением патогенов эффективен только тогда, когда персонал, работающий в лаборатории, целиком понимает смысл проводимых мероприятий и неукоснительно следует рекомендациям.
- Что нового в фармацевтической водоподготовке? Новая антикризисная линейка оборудования

В статье представлены современные решения для приготовления, хранения и распределения воды для фармацевтического использования в свете последних изменений нормативных требований. Авторы, сотрудники компаний группы ВWT,-делятся опытом работы на российском рынке и предлагают оптимальные решения...
- Практические аспекты организации ESD-защиты предприятия. В помощь ESD-координаторам. ESD-измерения

При рыночной экономике, в условиях которой мы с вами ведем свою деятельность, основой выживания и дальнейшего развития при неизбежной конкуренции является высокое качество продукции, которое является следствием качества процессов производства. В радиоэлектронной промышленности невозможно выпускать продукцию, не обращая внимания на качество.
- Создание чистых лабораторных помещений на арендованных площадях

В настоящее время аналитические исследования в области нанотехнологии приобретают превалирующее значение с экономической точки зрения, и эта тенденция находит свое отражение в росте потребности в создании современных лаборатории с контролируемой чистотой воздушной среды. Такие лаборатории создаются в производственных, корпоративных исследовательских центрах
- Уникальный SPF-виварий с чистыми помещениями в Академгородке г. Новосибирска

Сравнительно недавно произошло поистине эпохальное событие, которое задало вектор научных исследований на многие десятилетия вперед: в 2001 г. две конкурирующие научные команды (Международная организация по изучению генома человека — HUGO и Celera Genomics) объявили о первых...
- Анализ общего органического углерода выявляет изменения в химии воды

Анализатор общего органического углерода (ТОС) с прямым кондуктометрическим измерением подает оператору аварийный сигнал о возможном выбросе тригалогенометана (ТНМ) в воду фармацевтического качества
- Камеры с вертикальным однонаправленным потоком воздуха для работы с сыпучими веществами Pharmacon™ фирмы ESCO (Сингапур)

Неблагоприятное воздействие на человека и (или) на состояние здоровья будущих поколений могут оказывать различные по своей природе факторы среды обитания - биологические (вирусные, бактериальные, паразитарные и т.д.), химические (аэрозоли, пары и взвеси различных токсичных...
- Методология проведения валидации очистки оборудования

В статье предложены методы определения остатков моющих средств и приводится обзор результатов валидации хроматографического метода определения следов детергента LpHse с поверхности производственного оборудования.
- Критический взгляд на валидацию процесса очистки

Проведение валидации процесса очистки является необходимым условием для производства множества дорогостоящих продуктов. Важные этапы программы валидации очистки могут быть разными в зависимости от типа производства, а также от конкретного рассматриваемого продукта.
- Системы доставки химреактивов. Особенности аттестационных испытаний

Современная микроэлектроника развивается по пути уменьшения топологического размера интегральных микросхем. При этом процессы жидкостной химической обработки (ЖХО) пластин по-прежнему играют важнейшую роль в технологии производства микросхем.
- Нержавеющая сталь в системах водоподготовки для фармацевтических производств

Исторически сложилось так, что благодаря своему уникальному составу, имеющему гигиенические качества и устойчивость к химическим веществам, нержавеющая сталь находит активное применение в фармацевтическом производстве.
- Оптимизация процесса фильтрации в системе подготовки воздуха полупроводниковых производств

Исторически сложилось так, что контроль летучих молекулярных загрязнений (АМС - Airborne Molecular Contamination)1 в воздушной среде полупроводниковых производств был введен в практику для решения уникальных проблем, удаления нежелательных примесей и контроля коррозии металлических покрытий, протекающей под воздействием этих примесей.
- Мембранные технологии для водоподготовки в фармацевтике и медицине

Фармацевтические производства и медицинские учреждения являются одними из важнейших потребителей воды высокого качества. Вода очищенная, вода высокоочищенная, вода для инъекций, вода для гемодиализа, вода дистиллированная...
- Надлежащая очистка одежды как обязательный компонент технологии чистоты

В последние годы быстро увеличивается количество промышленных предприятий в самых различных отраслях хозяйства, которые производят продукцию в чистых помещениях или контролируемых средах.
- Руководство по аспектам валидации процессов очистки на производстве активных фармацевтических ингредиентов

Уважаемые читатели! Под таким названием АНО «ФАРМСТОЙ ГРУПП - Центр профессиональной подготовки» выпустил брошюру, представляющую собой перевод «Руководства по аспектам валидации процессов очистки на производстве активных фармацевтических ингредиентов», подготовленного в декабре 2000 г.
- Современные технологии очистки сточных вод производства СБИС

Сокращение поступления отходов производства сверхбольших интегральных микросхем (СБИС) в окружающую среду является важнейшей задачей. В целях предупреждения загрязнения окружающей среды через систему канализации необходима очистка сточных вод до установленных норм.
- Болезни высокой чистоты. Реферат статьи Б. Жукова

Под таким названием в мартовском номере журнала «Вокруг света» вышла статья Бориса Жукова, которая представилась Редакции очень интересной именно с «точки» зрения на чистоту.
2/2009 (30) апрель-июнь
- К вопросу об актуальности разработки современной отечественной нормативной базы в области подготовки технологических сред для производства СБИС (Часть 2)

По мнению авторов статьи, данная публикация является обращением и предложением к ведущим российским производителям ЭКБ и организациям, осуществляющим методическое руководство в указанной области, дать свои предложения и рекомендации по определению...
- Все на выброс

Фармацевтические и биотехнологические производители выбирают одноразовые системы асептического розлива и укупорки для снижения себестоимости продукции и повышения эффективности производства при строгом соблюдении требований FDA
- Кик обеспечить энергосбережение за счет параметров воздушных потоков в чистых помещениях

Проектируя или строя чистые помещения и связанные с ними здания и сооружения, мы оказываемся лицом к лицу с совершенно особым деловым климатом, уникальной атмосферой.
- Газовыделения из конструкционных материалов

Химическое загрязнение технологической среды в настоящее время является одним из основных обсуждаемых вопросов при изготовлении микросхем.
- Руководство для приобретения оборудования и чистых помещений, бывших в употреблении

В период финансовых затруднений всегда более актуальным становится размещение капитала в государственных ценных бумагах, т.е. акционирование, причем процесс этот имеет тенденцию к расширению.
- Высокие требования к чистоте поверхностей

Оценка чистоты поверхности занимает в контролируемой производственной среде важное место. В целях соблюдения надлежащих гигиенических требований к процессу необходимо постоянно контролировать чистоту критических поверхностей, с которыми возможен контакт загрязнителей, и технических поверхностей вблизи продукта.
- Сертификация боксов биологической безопасности II класса

В данной статье рассматриваются особенности конструкции и некоторые аспекты эксплуатации Боксов биологической безопасности (БББ) II класса. Описана процедура валидации БББ.
1/2009 (29) январь-март
- Оценка рисков при анализе соответствия производства требованиям GMP

Категория «Продукт» модели должна содержать факторы, которые связаны с внутренними свойствами лекарственного средства, т.е. факторы, воздействие которых может привести к изменению свойств готового лекарственного продукта.
- Валидация процессов. Новый подход FDA

18 ноября 2008 г. произошло важное событие для всех, кто производит фармацевтическую продукцию. В США был опубликован проект нового руководства FDA по валидации процессов при производстве лекарственных средств (Guidance for Industry. Process Validation: General Principles and Practices)
- Особенности проектирования фармацевтических предприятий в соответствии с правилами GMP

В данной статье мне хотелось бы рассказать о тех проблемах и ошибках, которые возникают в процессе проектирования новых и реконструкции действующих фармацевтических предприятий с целью приведения их в соответствие с требованиями Европейских правил GMP.
- К вопросу об актуальности разработки современной отечественной нормативной базы в области подготовки технологических сред для производства СБИС

В последние 20 лет развитие микроэлектроники в России осуществлялось очень медленными темпами. Предприятия использовали и реализовывали, в основном, разработки 80-х годов в области микронных технологий.
- Изолирующие системы: технология в процессе изменения

Новые лекарственные средства ставят все новые требования к защите продукта и персонала, в связи с чем индустрия чистых помещений постоянно развивается, стремясь решать эти новые задачи в двух ключевых областях - на фармацевтических предприятиях и в больничных аптеках, занимающихся приготовлением стерильных препаратов.
- Использование RABS и изоляторов в фармацевтической промышленности

Изолирующие технологии обеспечивают создание чистых зон не только для розлива и упаковки фармацевтической продукции, но и для защиты операторов
- Применение статистики при измерении количества частиц и в расчетах по стандартам

Понимание статистических закономерностей, лежащих в основе классификации чистоты воздуха, может помочь в проектировании и поддержании технологической среды чистого помещения
- Счетчики частиц и их основные характеристики

Суть любого определения чистого помещения сводится к тому, что количество аэрозольных частиц в нём поддерживается в определённых пределах, причём по численному значению счётной концентрации частиц известного размера можно сделать вывод о классе чистоты этого помещения.
4/2008 (28) октябрь-декабрь
- Оценка рисков при анализе соответствия производства требованиям GMP

В современном понимании риск представляет собой сложное явление, имеющее множество несовпадающих, а иногда противоположных реальных основ. Это, в свою очередь, обусловливает возможность существования нескольких определений понятий риска, основывающихся на различных точках зрения.
- Устраняем все противоречия

Эффективная программа мониторинга окружающей технологической среды начинается с интерпретации применяемых международных стандартов
- Электродиализный метод умягчения и снижения щелочности воды

Предлагается новый, экологически чистый метод умягчения и снижения щелочности воды с его конструктивной реализацией. Метод разработан на основании практического опыта и экспериментальных работ.
- Применение стандарто SEMI F57 в полупроводниковом производстве для систем управления жидкостными потоками

Использование различных компонентов (трубок, вентилей, фиттингов) удовлетворяющих требованиям стандарта SEMI F57 (SEMI F57-0301 - Provisional Specification for Polymer Components Used in Ultrapure Water and Liquid Chemical Distribution Systems - Временная спецификация для полимерных компонентов...
- ТОС -анализаторы марки АТОС. Практика применения

Известно, что качество сверхчистой воды должно непрерывно контролироваться, поскольку такая вода стремится интенсивно поглощать из соприкасающихся с ней конструкционных материалов и сред органические и другие примеси.
- Борьба с биопленками

Оптимальные программы санитизации должны активно внедряться на ранней стадии процесса производства
- Рекомендуемый документ IES-RP-CC003.2: «О системе одежды для чистых помещений и связанных с ними контролируемых сред» - современное руководство для разработчиков, производителей и пользователей одежды

Круг и количество предприятий высоких технологий, которые осуществляют свою деятельность в чистых производственных условиях, стремительно расширяется.
- Усилия по обеспечению пожарной безопасности чистых помещений продолжаются

Применение пожаробезопасных строительных материалов и оборудования наряду с соблюдением стандартов пожарной безопасности сделали индустрию чистых помещений более безопасной и предсказуемой относительно стоимости ущерба от возможных пожаров
3/2008 (27) июль-сентябрь
- Программа ЕSD контроля и современные стандарты ЕSD защиты

Каждый читатель журнала «Чистые помещения и технологические среды» когда-либо слышал или практически сталкивался с разрядами статического электричества ESD...
- Уборка чистых помещений

Продолжение главы «Уборка чистых помещений» из книги В.Уайта «Технология чистых помещений. Основы проектирования, испытаний и эксплуатации». Начало главы читайте в номере 2/2008 г.
- Уборка чистого помещения

Для поставщиков и потребителей расходных материалов для чистых помещений важны два основных принципа: расходные материалы должны выполнять свою функцию, и их использование должно быть рентабельным.
- Одноразовые решения

Одноразовые перчатки из поливинилхлорида (ПВХ) считались идеальной альтернативой перчаток из латекса, вызывающего аллергические реакции, и служили хорошей защитой для персонала, но автор доказывает, что этот выбор не идеален.
- Мониторинг установок сверхчистой воды

Эксплуатация установок получения сверхчистой воды на всех стадиях ее обработки требует наличия датчиков для контроля многих параметров -содержания в воде частиц, общего органического углерода (ТОС), кислорода и озона.
- Глобальный подход к валидации очистки

Глобальный или целостный подход к валидации очистки можно выработать только с помощью четко сформулированной методологии.
- СІР системы имеют решающее значение для контролируемой и рентабельной очистки оборудования

Очистка на месте (clean-in place), повсеместно известная под термином СIР, является автоматизированным методом очистки технологического оборудования без его демонтажа с применением валидированных процедур.
- Чистота поверхности

Мониторинг частиц на готовом изделии является важной составной частью процесса контроля загрязнений во многих отраслях промышленного производства.
- Определение чистоты поверхностей

В связи с быстрым развитием современных технологий и миниатюризацией устройств во многих высокотехнологичных отраслях чистоте поверхностей уделяется все большее внимание.
1/2008 (25) январь-март
- Методы контроля загрязнений в сжатых газах

Контроль микрочастиц в сжатых газах является ключевым моментом для фармацевтической отрасли. Но, как объясняет Джейсон Келли, использование методов контроля в соответствии с требованиями стандарта ИСО 8573 для разного рода газов имеет много аспектов.
- Экспресс-методы для микробиологического анализа (реферат статьи)

Статья Питера Болла, опубликованная в одном из последних номеров журнала Cleanroom Technology, касается важных вопросов применения новых экспресс-методов для проведения микробиологического мониторинга производственной среды, в том числе и чистых помещений, а также для контроля качества лекарственных средств.
- Анализ общего органического углерода в сверхчистой воде

Современные технологические процессы, связанные с внедрением высоких технологий в микроэлектронике, фармацевтике, биотехнологии, химии и других отраслях промышленности используют в качестве технологической среды воду с высокой степенью очистки.
- «Ржавчина» и фармацевтические системы водоснабжения

Эта статья написана в ответ на рост числа фармацевтических компаний, которые находят «ржавчину» в своих системах хранения и распределения сверхчистой воды.
- В воде есть жизнь

Производители фармацевтической продукции контролируют качество систем водоснабжения, заботясь о здоровье и хорошем самочувствии конечного потребителя
- Производство сверхчистой воды: взгляд изнутри

С повышением требований к количеству и качеству воды, не содержащей примесей, растет потребность в инновационных технологиях и усовершенствованных конструкциях, предлагающих новые возможности для ряда отраслей промышленности, потребляющих сверхчистую воду.
- Выбор наиболее подходящего расположения точек отбора проб для взвешенных в воздухе частиц, не являющихся микроорганизмами

В статье определяются основные факторы, влияющие на выбор оптимального расположения точек отбора проб, используемых для мониторинга технологического процесса
- Новая редакция Приложения 1 (Производство стерильных лекарственных средств) к европейским GMP

В № 3 нашего журнала за 2007 год была опубликована статья английского специалиста Джона Нейджера «Европейские принципы стерильного производства», в которой он подробно обобщил и сформулировал целую серию поправок...
- Стандарт ISO 14644-3:2005 «Чистые помещения и связанные с ними контролируемые среды. Часть 3. Методы измерений»

В этом номере журнала завершается публикация раздела стандарта ISO 14644-3:2005 «Чистые помещения и связанные с ними контролируемые среды. Часть 3. Методы измерений», посвященного измерению взвешенных в воздухе частиц
4/2007 (24) октябрь-декабрь
- Выбор датчиков скорости воздуха для мониторинга ламинарного потока (реферат статьи)

Реферат статьи Вальтера Хольша, опубликованной в журнале ReinRaumTechnik, 2/2006
- Собственное или контрактное производство

С необходимостью решить, производить ли продукт самостоятельно или передать производство поставщику услуг, сталкиваются все небольшие фармпроизводители
- Контроль содержания частиц в чистых помещениях

На смену коллекторам пришел непрерывный пробоотбор в каждой точке...
- Валидация модернизированных производств

Стремление фармацевтической промышленности к максимально эффективному производству и снижению производственных издержек обусловили повышенный интерес к многократному использованию и модернизации уже существующих производственных мощностей и имеющегося производственного оборудования.
- Протокол (регламент) чистого строительства

Концепция чистого строительства в общем виде отражена в ГОСТ Р ИСО 14644-4-2002 «Чистые помещения и связанные с ними контролируемые среды. Часть 4. Проектирование, строительство и ввод в эксплуатацию»...
- Борьба с электростатическими эффектами в чистых помещениях

Окружающая среда чистых помещений нуждается в защите от электростатических эффектов, т.е. явлений, вызываемых статическим электричеством. К ним относятся: электростатическое заряжение (ESC - Electrostatic Charge), электростатический разряд (ESD - Electrostatic Discharge) и электростатическое притяжение...
- Ультрафиолетовое излучение и его применение в чистом помещении

Чистые помещения, используемые в медицинских целях, в производстве пищевых продуктов, лекарственных средств, изделий медицинского назначения, в биотехнологической отрасли и для исследования животных, чувствительны к биологическому ...
- Стандарт ISO 14644-3:2005 «Чистые помещения и связанные с ними контролируемые среды. Часть 3. Методы измерений»

В этом номере журнала продолжается публикация стандарта ISO 14644-3:2005 «Чистые помещения и связанные с ними контролируемые среды. Часть 3. Методы измерений».
3/2007 (23) июль-сентябрь
- Профессионализм в фармацевтическом производстве

Настоящая статья представляет собой продолжение рассказа о результатах международного конкурса ІБРЕ «Предприятие года», первая часть которого опубликована в нашем журнале №1/2007
- Одноразовые ферментеры -новый подход к управлению рисками при производстве лекарственных средств

Технологическое оборудование, используемое при производстве лекарственных средств (ЛС), представляет собой сложные и дорогостоящие технические системы, эксплуатация которых связана с разнообразными рисками. К важнейшим из них относятся риски загрязнения продуктов посторонними микроорганизмами.
- Практический подход к проведению испытаний дезинфицирующих средств

Дейв Скотт, главный управляющий, и Брайан Александер, директор по качеству и регулятивным вопросам отдела фармацевтических услуг компании Tepnel Scientific Services, обсуждают методы проведения испытаний дезинфицирующих средств для фармацевтического сектора промышленности
- Анализ рисков при проектировании, строительстве и эксплуатации фармацевтических производств

Основной целью управления качеством является предупреждение несоответствия продукции заданным требованиям и рекламаций на нее. Эффективным методом решения этой задачи является анализ рисков. Под анализом рисков понимается метод оценки и описание критических параметров при функционировании оборудования и процессов
- Будущее фильтровентиляционных модулей (ФВМ)

В последнее время в проектировании и строительстве чистых помещений стали популярными относительно простые устройства, обеспечивающие подачу отфильтрованного воздуха в помещения высоких классов чистоты, т.н. фильтро-вентиляционные модули (ФВМ), известные в зарубежной литературе как FFU (Fan Filter Unit).
- Приборное оснащение подразделений контроля чистых производственных помещений

Компания «Клинрум Инструменте» специализируется на поставке приборов и оборудования для контроля различных характеристик чистых производственных помещений.
- Европейские принципы стерильного производства

Консультант по чистым помещениям Джон Нейджер высказал на страницах журнала Cleanroom Technology свои ожидания от пересмотра Приложения 1 к GMP ЕС «Производство стерильных медицинских продуктов», который планируется этим летом, и спрашивает: будет...
- Осаждение частиц на поверхностях чистых помещений

Специалистам, работающим в сфере высоких технологий и связанным с контролем чистоты производственной среды, знаком международный стандарт ISO 14644, большинство частей которого уже опубликовано и активно используется в практической деятельности.
- Стандарт ISO 14644-8:2006 «Чистые помещения и связанные с ними контролируемые среды. Часть 8: Классификация летучих молекулярных загрязнений»

Соответствие требованиям классификации (класс ISО-AМС), заданным заказчиком, подтверждается путем проведения ряда измерений, согласованных между заказчиком и поставщиком, и предоставлением документации по результатам и условиям их проведения.
- Стандарт ISO 14644-3:2005 «Чистые помещения и связанные с ними контролируемые среды. Часть 3. Методы измерений»

Мы продолжаем знакомить читателей с переводом стандарта ISO 14644-3:2005 «Чистые помещения и связанные с ними контролируемые среды. Часть 3. Методы измерений». В этом номере журнала помещен перевод раздела стандарта, посвященного наиболее важным измерениям в чистых помещениях - измерениям размеров и счетной концентрации взвешенных в воздухе частиц.
2/2007 (22) апрель-июнь
- Поведение кремниевой кислоты в процессе подготовки сверхчистой воды

С развитием микроэлектроники, нанотехнологии, оптоэлектроники требуется все большее количество технологических сред с самой высокой степенью очистки. Наиболее востребованной из них является сверхчистая вода. Одним из самых трудноудаляемых элементов в процессе подготовки...
- Оборудование компании «Миллипор» для микробиологического мониторинга

Анализ воздуха на содержание микроорганизмов имеет определенную специфику. Поскольку содержание микрофлоры в воздухе гораздо ниже, чем в жидкости, для получения адекватных результатов необходимо анализировать большой объем воздуха.
- Микробиологический мониторинг
Планирование программы микробиологического контроля является ключевым моментом работы в условиях чистой зоны или асептического фармацевтического производства. Колин Бут, вице-президент по науке и технологии компании Охоid, в своей статье приводит основные принципы стратегии микробиологического мониторинга.
- Эффективность испытания дезинфицирующих средств по нормам EN в рамках норм FDA для фармацевтической промышленности

Производственная гигиена играет большую роль во многих сферах, т.к. она напрямую связана с качеством и надежностью производимого продукта. С ростом значения гигиены в технологических процессах повышаются и нормативные требования, а с усилением глобализации и связанной...
- Высокие технологии и современное оборудование ESCO для оснащения чистых помещений

Уже ставший классическим в современной международной практике модульный метод монтажа чистых комнат позволяет создать чистые помещения Классов 3 - 9 по ГОСТ Р ИСО 14644-1:2000. Напомним, что чистые помещения - это помещения...
- Использование процессного подхода при производстве лекарственных средств. Из опыта производства альбумина на Липецкой областной станции переливания крови

В статье приводятся результаты применения функциональной модели процесса производства альбумина, разработанной в Липецкой областной станции переливания крови, на основе методологии IDEFO.
- О целесообразности антимикробной отделки тканей для технологической одежды

Сохранение микробиологической чистоты в производственных помещениях химико-фармацевтической промышленности является очень важной задачей. Поскольку основным источником микробных загрязнений является...
- Антимикробная обработка для одежды из текстиля для чистых помещении

Пользователи стерильных помещений часто задают себе вопрос, касающийся одежды для чистых помещений: «Является ли дополнительная антимикробная обработка этой одежды целесообразной или излишней?»
- Стандарт ISO 14644-8:2006 «Чистые помещения и связанные с ними контролируемые среды. Часть 8: Классификация летучих молекулярных загрязнении»

В чистых помещениях и связанных с ними контролируемых средах регулируется загрязнение воздушной среды аэрозольными частицами до уровней, соответствующих работе в условиях, чувствительных к такому виду загрязнения.
- Особенности применения международных стандартов в современных условиях производства

Ответ на первую часть вопроса достаточно прост. В настоящее время наиболее авторитетными нормативными документами в области чистых помещений являются документы Международной Организации Стандартизации...
1/2007 (21) январь-март
- Фармацевтический инжиниринг: зачем и как это делается

Современное толкование понятия «фармацевтический инжиниринг» гораздо шире, нежели выполнение расчетов и чертежей по проектированию фармацевтического производства, которые в нашей системе образования принято называть, в частности...
- Риск загрязнения. Перенос расходных материалов в чистое помещение

В Приложении 1 ЕU GМР говорится: «Перенос предметов в помещение и из помещения является одним из основных источников загрязнения» [1 ]. В данной статье речь идет о предметах, переносимых в чистое помещение или в другие подобные зоны, создавая при этом риск загрязнения, который можно легко упустить из виду. Предлагаются также способы минимизации этого риска.
- Лидеры на современном технологическом рынке: ламинарные шкафы и боксы биологической безопасности ЕSCО

Развитие современных технологий и прогресс в различных областях науки и техники от фармацевтики и микробиологии до микроэлектроники и полупроводниковой промышленности определяют высокие требования к правильному оборудованию рабочего места в условиях работы в чистых зонах.
- Использование и рынки сбыта устройств с чистой средой

Обычно под устройствами с чистой средой (cleanroom devices) понимают модульные системы с ламинарным потоком, называемые также чистыми лабораторными или рабочими местами (cleanroom benches). В то же время это определение можно распространить и на другие устройства...
- (Реферат статьи) Мониторинг молекулярного загрязнения воздуха (АМС)

Контроль количества и размера частиц в воздухе является неотъемлемой частью поддержания чистоты производственной среды, однако такого контроля явно недостаточно для получения информации о химических загрязнителях воздушной среды на производствах, где такого типа загрязнители, распространяющиеся по ...
- Стандарт ISО 14644-8:2006 «Чистые помещения и связанные с ними контролируемые среды. Часть 8: Классификация летучих молекулярных загрязнений»

В прошлом году международная организация по стандартизации (ISO) приняла новый стандарт ISO 14644-8: «Чистые помещения и связанные с ними контролируемые среды. Часть 8: Классификация летучих молекулярных загрязнений»
- Стандарт ISО 14644-3:2005 «Чистые помещения и связанные с ними контролируемые среды. Часть 3. Методы измерений»

Мы продолжаем публиковать переводы отдельных разделов стандарта ISO 14644-3:2005. В этом номере журнала помещены материалы, посвященные измерениям времени восстановления состояния чистого помещения и проверке герметичности ограждающих конструкций чистых помещений. Это пока еще сравнительно редко встречающиеся в отечественной практике виды измерений, однако их важность не вызывает сомнений.
4/2006 (20) октябрь-декабрь
- RАВS - альтернативный подход к аппаратурному оформлению критических процессов в фармацевтическом производстве

Снижение риска загрязнения продукта, например, при асептическом наполнении в производстве стерильных лекарственных средств, может достигаться с помощью различных технических средств.
- (Реферат статьи) Салфетки для протирки. Варианты использования и эффективность их очищающей поверхности

Перед началом процедуры очистки важно придать протирочным материалам в форме салфетки, используемым для очистки, надлежащую форму, а именно такую, которая позволяет пользователю удобно держать ее в руке и совершать такие движения по загрязненной поверхности, которые способствуют максимально эффективному удалению загрязнения.
- Очистка на микронном уровне для чистых помещений

Ультразвуковая очистка известна уже более сорока лет, но ее относительно редко применяют в технологии чистых помещений, и это довольно странно, если учесть, что такая очистка очень эффективна. Такое положение можно объяснить отсутствием знаний об ультразвуковом воздействии или просто отсутствием информации на эту тему.
- (Реферат статьи) Взгляд в будущее мониторинга летучих молекулярных загрязнений воздушной среды чистых помещений

По мере роста предприятий, использующих металлизацию медью и пластины 300 мм, а также по мере миниатюризации элементов до 65 нм требования к мероприятиям по защите от летучих молекулярных загрязнений становятся более строгими.
- Управление статической электризацией

Статическое электричество в чистых помещениях проявляется в виде электростатического заряжения (ESC -Electrostatik charge) и электростатических разрядов (ESD - Electrostatic discharge) и квалифицируется как один из видов загрязнений производственной среды. В настоящей статье показываются пути решения проблемы с помощью технологического оснащения полупроводникового производства.
- Одежда одноразового употребления: использование и рынки

В данной статье уделяется внимание одежде одноразового использования: где и когда утилизируется такая одежда? Кто поставляет текстильные материалы? Кто поставляет обработанные изделия? Каков по величине рынок одноразовой одежды?
- Стандарт ISO 14644-3:2005 «Чистые помещения и связанные с ними контролируемые среды. Часть 3. Методы измерении». Измерения потока воздуха

Мы продолжаем знакомить читателей с переводом стандарта ISO 14644-3:2005. В этом номере журнала помещены разделы стандарта, посвященные измерениям потоков воздуха в чистых помещениях.
3/2006 (19) июль-сентябрь
- Оптимизация выбора стерилизующей дозы излучения при радиационной срерилизации медицинской продукции в современных условиях

Радиобиологическое изучение микрофлоры лежит в основе обоснования режимов радиационной стерилизации в промышленности. Среди существующих...
- Ферментеры. Современная практика выбора оборудования

Процесс ферментации является важнейшим элементом биотехнологического и биофармацевтического производств. На этой технологической стадии происходит биосинтез целевого продукта и, следовательно, во многом определяется производительность всей производственной линии.
- Дезинфекция - здесь есть над чем подумать

Дезинфекция - это процесс устранения патогенных и условно-патогенных микроорганизмов с предметов и объектов внешней среды. Основная задача дезинфекции - прерывание механизма передачи инфекции обеззараживанием различных объектов.
- Одежда многократного использования для чистых помещений. Часть 2

Роберт МакИлвейн президент и основатель компании McIlvaine Company, Нортфилд, Иллинойс. Его первая статья «Чистые помещения: мировые рынки» была опубликована в 1984 году.
- Особенности проектирования систем подготовки деионизованной воды для микроэлектроники

Вода применяется в большинстве технологических процессов изготовления полупроводниковых изделий, в частности, травлении и многократных очистках. Она для этих целей выбрана не случайно - ее отличает легкодоступ-ность, относительная дешевизна, она может быть очищена до высоких степеней чистоты, при этом...
- Психологическое благополучие работающих женщин

События повседневной жизни, несущие в себе радость или разочарование, отражаясь в нашем сознании, накапливаются в виде соответственно окрашенного аффекта.
- Боксы биологической безопасности

Эту статью целесообразно рассматривать в качестве справочного пособия. В ней даны основные понятия биобезопасности и представлена общая информация по всем типам боксов биологической безопасности. Информация собрана при помощи реальных пользователей, включая опытных микробиологов-практиков и инженеров.
- Приборы для измерения перепада давления

Из самого определения чистого помещения («помещение, в котором контролируется концентрация взвешенных в воздухе частиц и которое построено и используется так, чтобы свести к минимуму поступление, выделение и удержание частиц внутри помещения, и в котором, по мере необходимости, контролируются другие параметры, например, температура, влажность и давление»...
- Стандарт ISO 14644-3:2005 «Чистые помещения и связанные с ними контролируемые среды. Часть 3. Методы измерений»

Из приложения В «Методы контроля чистых помещений»
- О стандарте по одежде технологической

ГОСТ Р 52538-2006 «Чистые помещения. Одежда технологическая. Общие требования» внесен Техническим комитетом по стандартизации ТК 458 «Правила производства и контроля качества лекарственных средств».
2/2006 (18) апрель-июнь
- ISO, GMP и лекарственные средства для россиян

Не в том суть жизни, Что в ней есть, Но в вере в то, Что в ней должно быть.
И. Бродский,
Нобелевский лауреат
- Валидация и квалификация технологического оборудования

Валидация технологических процессов является одним из важнейших элементов системы обеспечения качества при производстве лекарственных средств (ЛС) и фармацевтически активных субстанций (ФАС). Руководства по GMP, действующие в России и за рубежом...
- Управление фармацевтическим предприятием на базе информационной системы MFG/PRO

Фармацевтическая промышленность в России в настоящее время развивается достаточно быстрыми темпами, выходя на качественно новый уровень развития производства, который требует соответствия единой производственной системы требованиям надлежащей производственной практики - GMP.
- Обеспечение санитарной безопасности систем водоподготовки для фармацевтической промышленности

Вода для производства лекарственных препаратов, косметических средств и биотехнологических продуктов должна соответствовать особым требованиям, регламентирующим ее химическую чистоту и отсутствие бактериального загрязнения. Поэтому при производстве и хранении воды необходимо предусматривать возможность санации, дезинфекции и стерилизации.
- Коррозионно-активные газы и газораспределительные системы в полупроводниковом производстве

В полупроводниковой промышленности используются различные виды специальных газов, включая газы, которые наряду с их высокой токсичностью, пожароопасностью и высокой химической активностью проявляют и коррозионные свойства.
- Одежда многократного использования для чистых помещении

Благодаря более продолжительному сроку службы применение одежды многократного использования для чистых помещений может сократить затраты на одежду. Изделия многоразового использования могут обеспечивать высокую степень защиты; в то же время одежда для чистых помещений с течением времени ухудшает свои качества из-за износа, стирки, сушки и стерилизации.
- Обзор. Фундаментальные основы практики счета частиц (в соответствии со стандартами ИСО 14644 1-3)

Когда покупатель собирается приобрести счетчик частиц, его обычно интересуют такие характеристики, как цена, качество, гарантийное и сервисное обслуживание.
- Визуализация воздушных потоков

В фармацевтическом производстве количество содержащихся в воздухе частиц и микробных загрязнений с размерами 0,5 мкм - 5 мкм не должно превышать установленную предельную концентрацию. Частицы указанного диапазона размеров очень хорошо переносятся воздухом, что означает, что в вентиляционных установках и чистых помещениях частицы следуют за потоком воздуха.
- Стандарт ISO 14644-3:2005 «Чистые помещения и связанные с ними контролируемые среды. Часть 3. Методы измерении»

Из приложения В «Методы контроля чистых помещений»
1/2006 (17) январь-март
- Получение воды сверхчистой с помощью непрерывной электродеионизации

При изготовлении интегральных микросхем кремниевые пластины часто промываются водой...
- Важность отраслевой модели системы менеджмента качества (СМК) в рамках внедрения GМР на предприятиях по производству лекарственных средств. Государственное нормативное обеспечение

Область управления качеством в Российской Федерации, и в особенности документарное обеспечение данной области нормативными документами государственного уровня начинает постепенно складываться и формироваться.
- Контроль утечки установленных воздушных фильтров в системе воздухоподготовки чистых помещений

Процедура проверки фильтра на наличие утечек (с использованием тестового аэрозоля) подтверждает правильность монтажа фильтров и отсутствие утечек во время работы системы. При этом метод проверки встроенных фильтров не следует путать с определением эффективности фильтров, которое проводится изготовителем фильтров (DIN EN 1822).
- Система фильтрации: проверка целостности в соответствии с ISО 14644-3

Новый стандарт ISO 14644-3 «Чистые помещения и связанные с ними контролируемые среды. Часть 3. Методы измерений» опубликован как проект (DIS) . В стандарте среди прочего описывается и метод проверки целостности фильтров. Теоретические объяснения взаимосвязей при этих измерениях точны, но в то же время достаточно сложны.
- Воздушные фильтры и международные стандарты

Во всем мире разрабатываются стандарты, относящиеся к производству фильтров. В данной статье, представляющей собой первую часть публикации, авторы рассматривают и дают комментарии к разработке стандартов для фильтров, используемых в центральных вентиляционных системах зданий и сооружений.
- Контакт с активным веществом исключен

Возрастающая активность современных лекарственных веществ требует увеличения степеней защиты. Торстен Белжер из компании Powder Systems («Порошковые технологии») предлагает некоторые решения для общих проблем, с которыми сталкиваются фармацевтические компании
- Определение остаточного содержания частиц в очищенной одежде для чистых помещений

Одежда для чистых помещений используется в первую очередь для защиты продукта, производимого в чистом помещении, от повреждения частицами и волокнами, выделяемыми человеком. Таким образом, основная задача одежды для чистых помещений — барьерная функция, причем сама одежда не должна быть источником выделения частиц.
- Body-Box-Test метод испытания на испытательном стенде

Статья посвящена описанию практического метода испытания различных типов одежды персонала на отделение (генерацию) частиц. При этом основное внимание уделяется воспроизводимости результатов.
- Атимикробные стратегии в чистых помещениях

«Чистка, чистка, чистка... дезинфекция, дезинфекция, дезинфекция!» — это заклинание для микробиологического контроля в чистых помещениях не является единственным решением при управлении проблемами, вызываемыми микроорганизмами. Понимание источников микробиологического загрязнения, образа существования микроорганизмов...
- Электродиализный метод очистки технических стоков в процессе производства микрофотоэлектроники

Рассмотрена схема электродиализной очистки технических стоков в процессе производства изделий микрофотоэлектроники. Проведен анализ технико-экономических параметров данной системы очистки.
4/2005 (16) октябрь-декабрь
- Ультрафильтрация, как метод производства апирогенной воды

Согласно 5-му изданию Европейской фармакопеи и «Руководству о качестве воды для фармацевтических целей» Европейского агентства по оценке медицинской продукции (ЕМЕА) дистилляция является единственным легальным методом для производства воды для инъекций.
- Ферментеры. Управление рисками при закупке

Ферментационное оборудование относится к ключевым средствам производства в биотехнологической промышленности. Поскольку именно в них протекает биосинтез целевых продуктов, то их качество и надежность определяют продуктивность всего технологического процесса.
- Модернизация систем водоподготовки с соблюдением правил GМР

Для расширения системы существующих трубопроводов из поливинилиденфторида (ПВДФ) производитель лекарственных средств применяет бесшовную технологию сварки, тем самым, отвечая ужесточающимся требованиям к производственной чистоте и качеству продукции
- Современные требования к качеству воды для фармацевтических целей

Данная статья посвящена обзору современных требований, предъявляемых к качеству воды для фармацевтических целей ангро (вода очищенная, вода высокой степени очистки, вода для инъекций) ...
- Перекрестное загрязнение: переход на условия нового нормативного регулирования

Недавние изменения, как в европейском, так и в американском фармацевтическом регулировании постепенно вытесняют подход к поэтапному контролю качества и обеспечению качества на подход, основанный на идеологии контроля рисков.
- Технологическая одежда - необходимый компонент технологической чистоты
Всего 10 лет назад чистые производственные помещения использовались преимущественно в высокотехнологичных отраслях промышленности, таких как микроэлектроника, радиоэлектроника, производство точной оптики, биотехнология и фармацевтика. - IESТ выпускает обновленные методические рекомендации по испытанию ULРА-фильтров

Институт исследования окружающей среды и технологии (Institute of Environmental Sciences and Technologies - IEST) издавна был лидером в создании документации по фильтрам для чистых помещений и проведению испытаний фильтров.
- Фильтры для чистых помещении: спрос и предложение -анализ рынка

Эта компания первой опубликовала в 1984 году обзор «Cleanroom: World Market» («Чистые помещения: мировой рынок») и по сей день продолжает публиковать данные рынка и техническую информацию об индустрии чистых помещений.
3/2005 (15) июль-сентябрь
- Спрос на чистые помещения в пищевой промышленности во всемирном масштабе

Спрос на чистые помещения в пищевой промышленности в мире растет параллельно с ростом потребления готовых к употреблению блюд и продуктов вследствие высоких требований к чистоте производственной среды при их производстве.
- Ферментеры - анализ и управление рисками

Ферментеры являются важнейшими средствами производства в биотехнологической и биофармацевтической отраслях промышленности. Именно в них протекают процессы биосинтеза целевых продуктов.
- Система порта быстрой передачи обеспечивает биологическую безопасность

По словам Тима Коулза из фирмы Фарминокс Изолейшн порт с двойными дверями, изначально разработанный для обеспечения быстрого асептического перемещения, также подходит для размещения опасных веществ.
- Хранение и распределение воды для фармацевтических целей -холодная или горячая система?

Задачи системы хранения и распределения Воды очищенной, Воды сверхочищенной и Воды для инъекций идентичны. Система хранения и распределения должна поставлять очищенную в установке воду в нужный момент, в нужном количестве, нужного качества и с нужной температурой ко всем точкам потребления.
- Возможные пути развития микробиологических методов анализа в фармацевтической промышленности

Важность микробиологического контроля в фармацевтической промышленности обусловливает необходимость глубокого понимания его роли среди фармакопейных требований, идет ли речь о готовых стерильных или нестерильных продуктах, активных субстанциях и вспомогательных материалах.
- Очистка водорода: сравнение эффективности никель/титановой и палладиевой технологий

Сверхчистый водород необходим как для действующих в настоящее время, так и для перспективных кремниевых и многокомпонентных полупроводниковых процессов, включая кремниевую эпитаксию и МОС-гидридные технологии.
- Новое качество китайской фармации

Согласно данным Государственного статистического управления Китая в январе-октябре 2004 года прибыль 23 ведущих государственных предприятий фармацевтической промышленности Китая составила 3,53 млрд. юаней...
- 15 факторов, влияющих на выбор проекта и стоимость строительства чистых помещении
Четкое представление о производственном процессе, который будет осуществляться в планируемом помещении, является непременным условием для выбора эффективного и рентабельного проектаНачало статьи читайте в №2/2005 г. *
2/2005 (14) апрель-июнь
- 15 факторов, влияющих на выбор проекта и стоимость строительства чистых помещении

Четкое представление о производственном процессе, который будет осуществляться в планируемом помещении, является непременным условием для выбора эффективного и рентабельного проекта
- Протирочные материалы: что нужно знать о них?

Как много загрязнений вносят в чистую среду протирочные материалы? Насколько хорошо они протирают? Данная статья призвана помочь пользователям чистых помещений выбрать наиболее подходящие протирочные материалы.
- Валидация критических процессов и зон

В предыдущей статье читатели журнала были ознакомлены с новейшими документами US FDA, использующими анализ рисков применительно к производству лекарственных препаратов [1].
- Новые модели счетчиков частиц фирмы LIGHTHOUSE

Американская компания Lighthouse Worldwide Solutions произвела настоящую сенсацию на рынке аэрозольных приборов, за неполные три года пройдя путь от первого выпущенного ею счетчика аэрозольных частиц до признанного лидера среди производителей оборудования для чистых производственных помещений.
- Газораспределительные системы для субмикронных технологии

Создание за рубежом высокоразвитой индустрии сверхчистых газов было вызвано, прежде всего, увеличивающимися объемами их потребления в микроэлектронике.
- Качество стерильных лекарственных средств аптечного изготовления - на уровень требовании национального стандарта

Производственные (межбольничные) аптеки, осуществляющие производство инфузион-ных растворов наряду с фармацевтическими предприятиями, в обозримом будущем, как нам представляется, будут продолжать играть важную роль в обеспечении населения необходимой номенклатурой этих лекарственных средств.
- О тенденциях развития электронного машиностроения

Традиционная ежегодная выставка SEMICON Europa 2005 прошла в Германии, в Мюнхенском выставочном центре с 12 по 14 апреля. На ней в трех залах (в 2000 г. в 5 залах, 2002 г. в 4-х, с 2004 г. в 3-х залах) была размешена экспозиция около 4000 фирм со всех континентов.
1/2005 (13) январь-март
- Воздух, вода и многое другое - чем измерить чистоту?

У нашего журнала сложился определенный круг рекламодателей, которые сотрудничают с редакцией на постоянной основе. Мы решили предоставить возможность этим фирмам более подробно рассказать о своей деятельности и надеемся, что эта информация будет полезна читателям.
- Система анализа рисков. Как наиболее эффективно соответствовать требованиям GMP?

В настоящее время российская фармацевтическая промышленность находится в условиях перехода к работе в соответствии с современными международными требованиями (GMP). На этом этапе отечественные предприятия вынуждены привлекать значительные ...
- Оценка стоимости строительства фармацевтического производства

Чтобы обеспечить прибыльность фармацевтического, биофармацевтического производства или научно-исследовательского комплекса, при его проектировании необходим детальный анализ расходов
- ФАГРАН - ваш путь к успеху

С 2003 года ООО «ФАРМСТРОЙ РК» группы компаний «ФАРМСТРОЙ» совместно с ФГУП «Центральное научно-конструкторское бюро» приступило к серийному выпуску гранулирующих установок псевдо-ожиженного слоя ФАГРАН, полностью соответствующих требованиям GМР.
- Особенности применения ФВМ в фармацевтической промышленности

Об особенностях использования ФВМ в фармацевтической отрасли мы попросили коротко рассказать Питера Ройтера, технического менеджера компании AAF International B. V.
- Опыт применения ФВМ в практике компании M+W Zander

Опытом применения ФВМ в практике компании M + W Zander, являющейся одной из ведущих в области чистых помещений и климатехники, мы попросили поделиться координатора проектов г-на Вальдемара Мундта, который коротко представил нам информацию об особенности и преимуществах концепции использования ФВМ.
- FFU- это просто ФВМ

В практике проектирования чистых помещений в последнее время мы часто участвуем в дискуссиях, связанных с применением фильтровентиляционных модулей (ФВМ).
- Системы воды очищенной

Марк Босли, менеджер по развитию фирмы Пьюрит, оценивает варианты очистки воды.
- Лечить не причиняя вреда

В данной статье авторы уделяют внимание аппаратному оснащению исследования инородных частиц и частиц оболочек капсул, используемых для приема внутрь лекарственных препаратов, выпускаемых в виде порошковых ингаляторов.
4/2004 (12) октябрь-декабрь
- Контроль загрязнений в минисредах и изоляторах

Мартин Деркс обсуждает новые решения, которые предлагает компания Lighthouse для оранизации многоточечной системы мониторинга в минисредах и изоляторах
- Модульные чистые помещения

Концепция модульных чистых помещений и локальных зон в практике создания контролируемой производственной среды воплощается в самых разнообразных вариантах — от ограждений с мягкими занавесями до чистых помещений контейнерного типа.
- Сверхчистая вода для сверхчистых помещений
Чистые помещения в фармацевтической промышленности и в здравоохранении обычно обеспечиваются водой, которая соответствует стандартам, представленным в различных фармако-пеях для воды для инъекций. - Система анализа рисков. Биологический опасный фактор
В статье рассматривается биологический опасный фактор и превентивные меры, позволяющие удерживать его под контролем. Приводятся конкретные примеры таких мер, эффективность которых подтверждена практикой эксплуатации чистых помещений фармацевтических производств. - Взгляд в будущее

Статья публикуется с разрешения редакции журнала Cleanroom Technology (www.cleanroom-fechnology.co.uk), September 2004, перевод Семеновой Е.Ю.
- Защита от статического электричества

Симон Хэтчер, руководитель проектного отдела компании Meech Static Eliminators, рассматривает достижения в области защиты от статического электричества.
- Вопросы обеспечения водой фармацевтических предприятий
Качество воды имеет большое значение на современном фармацевтическом предприятии. Вода используется практически на всех стадиях производства. Это мойка помещений и оборудования, санитарно-гигиенические цели, приготовление аналитических растворов, использование в качестве теплоносителя и хладагента, приготовление компонентов и готового продукта. - Как соответствовать современным требованиям GМР?

Заметным событием на 3 Международной Конференции «Инженерная практика GEP - основа GMP фармацевтических предприятий» было выступление вице-президента западногерманской фирмы Sartorius AG Карла Брахта.
3/2004 (11) июль-сентябрь
- Аттестация (квалификация) проекта чистых помещений

В начале текущего года на российском фармацевтическом рынке произошло знаменательное событие. Речь идет о вводе в эксплуатацию на ЗАО «Партнер» реконструированного производства субстанций пробиотиков.
- Комплексы чистых помещений для станций переливания крови

На современном этапе развития медицины деятельность специалистов службы крови не ограничивается переливанием «теплой» крови от донора реципиенту. Трансфузио-логия сегодня — это комплексное фракционирование крови, переливание продуктов ее разделения и приготовление на их основе лекарственных препаратов, создание банков стволовых клеток.
- Все стерто

Карен Россингтон, менеджер по маркетингу компании Shield Medicare, обсуждает протирочные материалы для фармацевтических чистых помещений и путь их выбора. При выборе протирочных материалов для разных зон чистого помещения нужно учитывать множество факторов.
- Очистка воздуха в вентиляционных системах общего назначения

Для обработки воздуха в чистых производственных помещениях обычно используют 3 — 4 ступени очистки. Настоящая статья содержит весьма полезную информацию по выбору, установке и замене фильтров грубой и тонкой фильтрации, предназначенных для 1-ой и 2-ой ступеней фильтрации.
- Специальные и технологические газы в полупроводниковой промышленности

Современное полупроводниковое производство характеризуется увеличением доли «сухих» процессов, ростом потребления различных видов газов и газовых смесей, расширением перечня контролируемых примесей в них и ужесточением контроля микрозагрязнений, уровень которых уже в недалеком будущем будет оцениваться величиной 100 -10 ppt (одна часть на триллион).
- Опыт использования технологии LonWorks при разработке систем управления инженерными сетями

Производственные комплексы, включающие чистые помещения, например, в микроэлектронике, фармацевтике, медицине и пр., имеют очень развитую систему инженерных систем, которые нуждаются в автоматизированном контроле и управлении.
- Шесть сигма

Реферат по публикации Cleanroom Technology
- Прибор для измерения биоаэрозолей.

Реферат по материалам фирмы TCI Inc.
- Счетчик ядер конденсации с использованием паров воды - model 3785. .

Реферат по материалам фирмы TSI Inc
2/2004 (10) апрель-июнь
- Контроль биозагрязнений в чистых помещениях основывается на анализе рисков
В сентябре прошлого года были приняты два новых международных стандарта: ISО 14698-1: 2003 и ISО 14698-2:2003 [1, 2]. Они имеют общее название «Чистые помещения и связанные с ними контролируемые среды. - Система анализа рисков. Опыт практического применения

Данная статья является второй в серии публикаций о системе анализа рисков НАССР. В предыдущей статье читатели журнала были познакомлены с историей создания системы НАССР, с используемой в ней терминологией и с принципами, на которых она основана [1].
- Правильный выбор конструкционных материалов -первый шаг к созданию сверхчистой газораспределительной системы

Сегодня трудно переоценить значение и роль газораспределительной системы в полупроводниковом производстве.
- Пора измерять общий органический углерод?
Пенни Бристоль из компании Ионике Инструменте утверждает, что, поскольку большинство фармацевтических лабораторий, следуя требованиям контролирующих органов, уже имеют анализаторы общего органического углерода (ТОС), их можно использовать и для валидации очистки (ВО), чтобы сэкономить время анализа и деньги на приобретение более специфичных анализаторов - Опыт эксплуатации установки электродеионизации в составе системы подготовки сверхчистой воды

Качество сверхчистой воды (СЧВ) для производства микросхем неразрывно связано с уровнем топологических норм: по мере увеличения степени интеграции возрастают и требования к воде.
- Новые тенденции в развитии микроэлектронного машиностроения

Очередная ежегодная выставка Semicon Europa 2004 состоялась в Германии в новом мюнхенском выставочном центре с 20 по 22 апреля. На ней в трех гигантских залах были размещены экспозиции около 5 000 различных фирм со всех континентов.
1/2004 (9) январь-март
- Новый взгляд на моделирование воздушного потока в чистых помещениях

Роберт П. Донован является инженером-технологом в Sandia National Laboratories и ежемесячно ведет колонку в журнале CleanRooms (www.cleanrooms.com)
- Системы контроля параметров чистых помещений и их соответствие CFR 21, часть 11

Морган Полен (Morgan Polen) является вице-президентом по прикладным исследованиям компании Lighthouse Worldwide Solutions, США, которая специализируется на системах контроля параметров чистых помещений для фармакологической и микроэлектронной промышленности, а также для производства жестких дисков.
- Система анализа рисков

В правилах GMP многих стран особое внимание производителей лекарственных средств обращается на необходимость выявления критических процессов и зон [1, 2, 3]. Более того, предписывается не только их выявление, но и постоянный контроль со стороны производителя.
- Специальные свойства одежды для чистых помещений
У специалистов, работающих для чистых помещений и в чистых помещениях, нет сомнений, что одежда - важный компонент технологии чистоты при эксплуатации этих помещений. Поэтому вопрос качества одежды для персонала актуален с момента появления самих чистых помещений. - Новая редакция приложения А (асептическое производство) к GMP EC

В прошедшем году в области контроля загрязнений произошло очень значительное событие, которое, по-видимому, полностью изменит подход к измерениям содержания аэрозолей в воздухе чистых помещений, используемых в фармацевтической промышленности и медицине.
- Высокоэффективные воздушные фильтры (HEPA и ULPA) - тестирование и классификация

В статье дан обзор действовавших недавно в различных странах и основывавшихся на различных критериях стандартов по определению эффективности HEPA- и ULPA-фильтров.
- Определение частиц в фармацевтических препаратах

Д-р Рольф Кляйне обсуждает вопрос определения содержания частиц в растворах и рассматривает требования к автоматизированным системам.
- Статическое электричество в чистых помещениях

В этом номере журнала мы начинаем публиковать материалы, касающиеся проблем, связанных с электростатическими эффектами, являющимися загрязнителями чистых помещений. В настоящей статье представлены основные термины и определения, касающиеся этой важной проблемы, а также методы контроля статического электричества.
- Стандарт ИСО 14644-3 представляет новый подход

Если тон некоторых предыдущих стандартов ISO граничил с приказным, то в проекте стандарта ISO 14644-3 он существенно изменился. Вместо обязательных предписаний, стандарт предлагает ряд рекомендуемых испытаний, среди которых пользователь может выбрать необходимые для применения.
4/2003 (8) октябрь-декабрь
- Дезинфекция чистых помещений. Современные требования

Дезинфекция чистых помещений относится к одним из наиболее важных процессов в биофармацевтической промышленности. Особое значение она приобретает в производстве стерильных лекарственных средств, т.е. там, где используются производственные помещения высоких классов чистоты.
- Напольные поливинилхлоридные покрытия для чистых помещений

При проектировании и строительстве чистых помещений часто встает проблема выбора подходящих материалов для их отделки, в частности полов.
- Компьютерные системы контроля параметров чистых производственных помещений

Оптические счетчики частиц аэрозолей - фотоэлектрические приборы, определяющие число частиц, прокаченных через измерительный объём прибора, путём подсчёта количества импульсов света, рассеянного каждой отдельной частицей...
- Концепции построения систем гарантированного электроснабжения в чистых помещениях

Более ста лет человечество использует электрическую энергию для своих нужд. Электрические приборы, агрегаты, устройства окружают нас на протяжении всей жизни и плотно вошли в нее.
- Подготовка технологического трубопровода

«При создании нового технологического трубопровода из нержавеющей стали, обязательным является понимание важности применения самых лучших материалов и технологий, чтобы гарантировать его чистоту при монтаже», — объясняет Стив Пурнелл.
- Чистые помещения 2013 года

Зарубежные эксперты представляют свое видение чистых помещений будущего
3/2003 (7) июль-сентябрь
- Валидация - что, где, когда?

Валидация является одним из наиболее сложных разделов Правил GMP. Сложность заключается в многозначности этого понятия, а также в том, что оно является новым для российских специалистов.
- Практическое руководство по расследованию причин микробиологического загрязнения

Как выявить причины микробиологического загрязнения и выработать долгосрочные и краткосрочные решения, позволяющие исключить такие дорогостоящие ситуации на вашем биотехнологическом или фармацевтическом производстве...
- Микробиологический мониторинг воздушной среды изолятора

Данная статья была опубликована в журнале Cieanroom Technology, № 4, 2003 и является сокращенным изложением содержания доклада, сделанного автором на конференции PDA* «Технология изоляторов с позиций пользователей», проходившей 29-30 апреля 2002 г. в США.
- Последняя разработка в области проверки чистоты поверхностей

Морган Полен (Morgan Polen), вице-президент компании Lighthouse Worldwide Solutions (США) по прикладным технологиям, сравнивает существующие методы определения чистоты поверхностей с новой разработкой, основанной на анализе цифровых изображений
- Технология получения чистой воды

В этом году редакция журнала готовит к изданию перевод книги «Проектирование чистых помещений», выпущенной издательством WHEY под общей редакцией хорошо известного нашим читателям шотландского исследователя в области технологии чистых помещений В. Уайта.
- Воздушные фильтры и стоимость рабочего цикла

Необходимость энергосбережения и снижения стоимости рабочего цикла (Life Cycle Cost — LCC) значительно возросли наряду с повысившимися требованиями улучшения качества воздуха внутри помещения и увеличения производительности.
- О техническом регулировании в сфере обращения лекарственных средств
18 апреля 2003 г. в целях реализации закона «О техническом регулировании» и распоряжения Правительства РФ №252-р от 28.02.03 г. приказом Госстандарта РФ №246 был создан ТК по стандартизации «Лекарственные Средства».
2/2003 (6) апрель-июнь
- Квалификация чистых помещений и зон

В статье приведена информация о порядке проведения контроля параметров воздушной среды в чистых помещениях и зонах при производстве лекарственных средств.
- Специальная подготовка баллонов - гарантия сохранения качества сверхчистых газов, применяемых в субмикронных технологиях

Цель настоящей статьи — обратить внимание отечественных производителей газов на проблему специальной тары (баллонов) для особо чистых газов, а также на методологию подготовки баллонов за рубежом.
- Микробиологический мониторинг

Петер Когер (компания PMT Parfikel-Messfechnik AG) обсуждает тему частого, продолжительного или непрерывного микробиологического мониторинга в фармацевтической промышленности
- Фильтрация воздуха при высоких температурах Реферат статьи Г. Мелгаарда и Т. Майерса

При фильтрации воздуха повышенной температуры возникает множество проблем, связанных с работой фильтров и контролем их целостности. Большинство стандартных процедур для чистых комнат и методик проверки НЕРА-фильтров в этом случае неприменимо и может привести к неустойчивой работе оборудования.
- Технология получения чистой воды

Пользователи чистых помещений потребляют процессную воду, забираемую обычно из общедоступных водных систем с широким спектром исходного качества, зависящего от самого источника воды.
- Практика «чистого строительства» чистых помещений

Практика эксплуатации чистых помещений требует, чтобы оператор прежде, чем войти в производственную зону с контролируемыми параметрами окружающей среды, должен пройти целый ряд стадий подготовки (например, переодевания и очистки). Строительство чистого помещения требует того же.
1/2003 (5) январь-март
- О реформе системы технического регулирования

27 декабря прошлого года утвержден Федеральный закон №184-ФЗ «О техническом регулировании»
- Измерение воздушных потоков в чистых помещениях: скорость; кратность воздухообмена или процент перекрытия фильтрами плоскости, перпендикулярной направлению потока? (реферат)
Для того, чтобы охарактеризовать воздушный поток, в первую очередь необходимо определить его тип. Воздушные потоки в чистых помещениях подразделяют на однонаправленные (ламинарные) и неоднонаправленные (турбулентные). - Валидация на практике

Большинство работающих в фармацевтической промышленности знают, что такое валидация и в целом неплохо разбираются в терминологиия...
- Предотвращение молекулярного загрязнения воздуха

Технологическое оборудование чистых помещений обычно создается с целью защиты персонала или производственного процесса от загрязняющих воздух частиц.
- Валидация фармацевтического производства

Минпромнауки России и Минздравом России с 1 июля 2000 года введён в действие Стандарт отрасли ОСТ 42-510-98 «Правила организации и контроля качества лекарственных средств (GMP)».
- Газовые распределительные системы для производства оптического волокна нового поколения

Производство оптического волокна относится к разряду высоких технологий и диктует высокие требования не только к технологическим средам, но к специальным инженерным системам...
- Повышение эффективности перехода российских предприятий к работе в соответствии с правилами GMP

Современное состояние российского рынка фармацевтических препаратов характеризуется жесткой конкурентной борьбой сотен отечественных и зарубежных производителей.
- «Время-деньги»

«Время - деньги». Эта хорошо известная формула в строительстве и запуске особочистых производств для микроэлектроники приобрела наиболее громкое звучание, когда стоимость нового стандартного производства перевалила за 2 млрд. долл. и для уровня технологии 0,1 мкм стала приближаться к отметке 3 млрд.
- Конференция АСИНКОМ XXI

9 - 10 декабря 2002 г. журналом «Чистые помещения и технологические среды» при организационной поддержке ГНЦА и ВНИИФТРИ была проведена очередная, вторая по счету, научно-практическая конференция АСИНКОМ XXI.
4/2004 (4) октябрь-декабрь
- «Квалифицированная» чистота

Для продажи фармацевтической продукции и продукции медицинского назначения на мировом рынке недостаточно просто производить их в условиях чистых помещений. Необходимо также продемонстрировать...
- Измерение микроорганизмов в воздухе - после долгих исследований проблемы еще остаются!

Дан обзор более чем шестидесятилетних усилий, направленных на разработку оборудования для измерения взвешенных в воздухе микроорганизмов. Показано, что до сих пор многие проблемы так и не решены и должны быть вынесены на обсуждение.
- Особенности проектирования систем вентиляции и кондиционирования воздуха для объектов здравоохранения

Системы вентиляции, отопления и кондиционирования воздуха (ВОК) должны обеспечивать оптимальные условия микроклимата и воздушной среды помещений больницы, родильного дома или другого стационара.
- История чистых помещений

В ноябре вышла в свет на русском языке книга авторитетного шотландского специалиста по чистым помещениям Б.Уайта «Технология чистых помещений. Основы проектирования, испытаний и эксплуатации», которую вы можете приобрести в редакции нашего журнала.
- Профессиональная уборка

С 22 по 25 октября 2002 г. в Центральном выставочном зале «Манеж» прошла 4-ая международная выставка «ИНДУСТРИЯ ЧИСТОТЫ 2002», в которой приняли участие более 70 компаний из 12 стран.
3/2002 (3) июль-сентябрь
- Эффективность фильтрации неоднородными волокнистыми фильтрами

Определен коэффициент проскока частиц через волокнистый фильтр с учетом влияния крупномасштабных флуктуаций плотности упаковки волокон. Учет указанной зависимости позволяет добиться лучшего...
- Фильтрация воздуха в XXI столетии

Обычно редакция публикует переводы материалов лишь из последних выпусков зарубежных журналов, однако для этой статьи было сделано исключение ввиду чрезвычайной важности затронутых в ней проблем.
- Особенности процесса очистки одежды для чистых помещений

Как известно, технологическая одежда является своего рода устройством (барьером и/или фильтром) с ограниченным собственным пылевыделением для локализации персонала (защиты технологической среды от частиц и микроорганизмов, выделяемых человеком) и сохранения заданного уровня чистоты воздуха в производственном помещении.
- Новая коллекция. Альтернативный материал для систем водоподготовки

Вода в фармацевтической технологии и биотехнологии является одним из самых важных базовых материалов для изготовления лекарственных препаратов. Сверх того, она очищает резервуары и приборы.
- Стандарты классификации чистых помещений

Стандарт ИСО 14644-1 был принят в 1999 г. и действует пока наравне с национальными стандартами и, в том числе, с Федеральным стандартом США 209. Однако срок параллельного действия стандартов заканчивается...
- Лазерная очистка: методы удаления субмикронных частиц

Развитие микроэлектроники идет по пути уменьшения размеров топологических элементов схем. При этом уменьшается и максимально допустимый размер частиц, которые могут присутствовать в воздухе при их производстве.
- Особенности проектирования чистых помещений для аэрокосмической отрасли. Интервью с генеральным директором ЗАО «Экопроект» А.Д.Гайдуковым

В последнее десятилетие в России технология чистых помещений начала интенсивно внедряться в аэрокосмическую промышленность. Первым предприятием, проектирующим такие чистые помещения, стало ЗАО «Экопроект».
- Новости из стран ближнего зарубежья

С 05 по 07 июня в г. Одессе проходил IV семинар «GMP-нормирование, обеспечение и контроль качества производства лекарственных средств, лицензирование оборота наркотических средств, психотропных веществ и прокурсоров».
- Европейский опыт российским предприятиям

Европейский опыт российским предприятиям
2/2002 (2) апрель-июнь
- Очистка газов в лини в точке использования

Предназначение очистителей - удалять гомогенные (молекулярные) примеси из газов. Как правило, основу очистителей составляют реакционноспособные компоненты, предназначенные для удаления таких примесей, как кислород и влага.
- Автоматизированные системы контроля и управления параметрами микроклимата для чистых производственных помещений

Описывается опыт реализации автоматизированных систем контроля и управления (АСКУ) параметрами микроклимата для чистых производственных помещений с сетевым принципом организации на базе проектно-компонуемых микропроцессорных станций.
- Чистота и алюминий - лучшее решение

Строительная компания «РОСТ» — известная строительная фирма Урала специали-зируюется в области проектирования и изготовления строительных алюминиевых конструкций.
- Технология обратного осмоса в фармацевтическом производстве (реклама НПК Медиана-фильтр)

Высокочистая вода является одним из ключевых элементов для обеспечения качества фармацевтической продукции и работы медицинских учреждений. Требования к ее качеству регламентируются фармакопейными статьями.
- Валидация чистых помещений и мониторинг их состояний

На протяжении последних лет, работая с различными фармацевтическими предприятиями в области консультаций по вопросам приведения производств к соответствию требованиям ОСТ 42-510-98 (GMP), мы столкнулись с некоторым...
- Сводная таблица классификации чистых производственных помещений по различным нормативным документам

Сводная таблица классификации чистых производственных помещений по различным нормативным документам
- Состояние нормативно-правовой базы для внедрения требований GMP в фармацевтическую промышленность и пути ее совершенствования

Состояние нормативно-правовой базы, регламентирующей функционирование медицинской и фармацевтической промышленности, в настоящее время можно оценить как неудовлетворительное и тормозящее, в какой-то мере...
- Европейские Правила GMP и стандарты ISO/TC209

Руди Гейллейт (Эйндховенская лаборатория DHV AIB по чистым помещениям и VCCN) обсуждает влияние вышеупомянутых европейских стандартов
- Управление качеством на производстве

В первые десятилетия XX века многие страны стали на путь интенсивного экономического развития и, одновременно с этим, изменилось отношение к проблеме качества продукции.
- Симпозиум «GMP - основа качества в фармацевтической промышленности»

Под таким названием в рамках «Петербургского диалога» 8-9 апреля 2002 г. в г. Веймар, Германия, состоялась встреча немецких и российских специалистов фармацевтической промышленности.
- О посещении международной выставки Semicon Europa 2002

В апреле этого года в Мюнхенском выставочном центре была проведена традиционная ежегодная выставка-симпозиум под названием SEMICON EUROPA 2002.
- Hi-Tech - высокий уровень технологий и стандартов мониторинга чистоты

Широкое освоение технологий высокого уровня (Hi-Tech) в России является ключевым звеном для предстоящего перехода отечественной промышленности от добычи и первичной обработки сырья к выпуску высококачественной продукции.
- Международный симпозиум по контролю микрозагрязнений

16 -ый международный симпозиум по контролю микрозагрязнений в этом году состоялся в г. Анахейме, пригороде Лос-Анжелеса (США, Калифорния) в период с 28 апреля по 1 мая.
1/2002 (1) январь-март
- Молекулярные загрязнения в атмосфере чистых технологических помещений микроэлектронных производств

В последнее время в зарубежной периодической печати, освещающей новости полупроводниковой промышленности, все чаще сообщается о необходимости проведения мониторинга молекулярных загрязнений в чистых помещениях (ЧП).
- Одежда для чистых помещений как сложная многослойная структура

Современная практика выбора текстильных материалов и конструкции одежды для ЧП предусматривает максимальную закрытость пододежного пространства. Это предопределяет практически полное отсуствие регулируемого тепло- и массообмена с окружающей средой и критические физиологические нагрузки на человеческий организм.
- Новые подходы к управлению качеством

Для каждого предприятия и для каждой отрасли качество представляет собой решающий инструмент по поддержанию и повышению конкурентоспособности.
- Современные направления в контроле аэрозольных микрозагрязнений
В последние годы в области контроля аэрозольных микрозагрязнений произошли заметные изменения, которые коснулись как устройства и конструкции самих приборов для измерения размеров и концентрации частиц, так и методических особенностей их применения. Обзору указанных тенденций развития аэрозольного приборостроения и посвящено настоящее сообщение. - Современный взгляд на обеспечение чистоты в субмикронных производствах СБИС

Обеспечение чистоты в микроэлектронном производстве является сложной многопараметрической задачей, которая охватывает весь технологический комплекс от специальной конструкции здания и технологии его возведения, проектирования и методов...
- Высоким технологиям - высокая мода

Предприятие «ЭКМА» было основано в 1991 году Киевским технологическим институтом легкой промышленности (теперь Киевский национальный университет технологий и дизайна) и тремя его сотрудниками.
- Отечественное оборудование для чистых технологий в здравоохранении и медицинской промышленности
Требования внедрения и использования чистых технологий в практическом здравоохранении и в медицинской промышленности по мере развития общества становится все актуальнее. - «БЛОК ВЕСТ ХОЛДИНГ» -Европейское качество российскому производителю

В последние годы фармацевтическая промышленность в России начала выходить на качественно новый уровень, который требует соответствия всех составляющих единой производственной системы требованиям надлежащей производственной практики - GМР.













